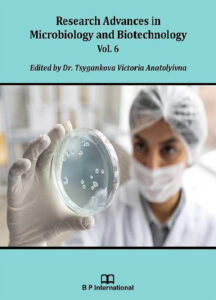

| 1971 | 1972 | 1973 | 1974 | 1975 | 1976 | 1977 | 1978 | 1979 | 1980 |
| 1981 | 1982 | 1983 | 1984 | 1985 | 1986 | 1987 | 1988 | 1989 | 1990 |
| 1991 | 1992 | 1993 | 1994 | 1995 | 1996 | 1997 | 1998 | 1999 | 2000 |
| 2001 | 2002 | 2003 | 2004 | 2005 | 2006 | 2007 | 2008 | 2009 | 2010 |
| 2011 | 2012 | 2013 | 2014 | 2015 | 2016 | 2017 | 2019 | 2020 | |
| 2021 | 2022 | 2023 | 2024 | 2025 |
 |
Производство низших олефинов. А. В. Степанов В книге приведены теоретические основы получения олефинов пролизом углеводородного сырья и основы математического моделирования процессов пиролиза и реакторов, даны конструкции трубчатих печей и основне принципы проектирования. Описаны способы получения продуктов высокой степени чистоты и технологические схемы современных этиленовых производств, а также трубопроводный, автомобильный, железнодорожный и водный транспорт этилена и способы его хранения. Рассмотрена экономика производства низких олефинов. Предназначена для научных и инженерно-технических работников химической и нефтехимической промышленности.
Document type / Вид документа : Книга Year / Рік видання : 1978 Place of publication / Місце видання: Київ Publisher / Видавництво : Наукова думка Author : А. В. Степанов Language / Мова: Російська Size / Кількість сторінок: 242с. Keywords / Ключові слова: олефины, пиролиз, пиролизные печи, пирогаз, етилен, экономика пиролиза УДК 655.642 |
 |
Химия тиолен –I, I – диоксидов. Т. Э. Безменова В монографии впервые в мировой литературе обобщены фактические данные в области химии ненасыщенных пятичленных циклических сульфонов- тиолен-I,I-диоксидов и их производных. Систематезированы данные о методах синтеза, физико-химических свойствах и реакционной способности этих соединений.Они рассмотрены как перспективные исходные вещества для синтеза различных насыщенных пятичленных циклических сульфонов – производных тиолан-I,I-диоксида, бициклических гетероциклов и других соединений. Приведены сведения о применении тиолен- и замещенных тиолан- I , I-диоксидов. Дан список известных тиолен- и тиолан-I , I-диоксидов, позволяющий судить о развитии отдельных направлений химии этого класса соединений. Для специалистов в области синтеза органических, гетероциклических и элементоорганических соединений, а также преподавателей, аспирантов и студентов химических факультетов.
Document type: Книга, Монография Year / Рік видання: 1981 Place of publication / Місце видання: Київ Publisher / Видавництво: Наукова думка Author / Автор : Т. Э. Безменова Language / Мова: Російська Size / Кількість сторінок: 292с. Keywords / Ключові слова: циклические сульфоны, тиоландиоксиды, тиолендиоксиды, алкоксилирование, аминирование, диоксотиоландитиокарбонаты, сульфокарботион. УДК 621.534 |
 |
Идентификация и моделирование объектов управления в нефтехимии. Р.Я. Ладиев, А.М. Манойло, Л.Н. Шкарапута, В.В. Даниленко Под редакцией кандидата технических наук А.М. Манойло В монографии на примере многоплановых исследований конкретных нефтехимических процессов изложены приемы и методы математического моделирования и идентификации, исследованы отдельные гомогенные, гетерогенные и гетерогенно-каталитические реакторные системы. Несомненный интерес представляют чисто методологические аспекты книги, особенно с позиций разработки автоматизированных систем управления технологическими процессами. Для инженеров, проектировщиков и исследователей, работающих в нефтехимической, химической, фармацевтической, лесохимической и пищевой промышленности. Будет полезна аспирантам и студентам старших курсов, специализирующимся в области автоматизации технологических процессов и химической кибернетики.
Document type: Книга, Монография Year / Рік видання: 1981 Place of publication / Місце видання: Киев Publisher / Видавництво: Вища школа Author : Р.Я. Ладиев, А.М. Манойло, Л.Н. Шкарапута, В.В. Даниленко Language / Мова: русский Size / Кількість сторінок: 183 с. Keywords / Ключові слова: кинетика, оптимизация, управление, жирные кислоты, алкилирование, алкенилянтарный ангидрид УДК 665.6 |
 |
Методические проблемы экономики развития и размещения нефтеперерабатывающей промышленности. В.Т. Скляр, В.А. Бугров., Е.И. Наумов АКАДЕМИЯ НАУК УКРАИНСКОЙ ССР ОТДЕЛЕНИЕ НЕФТЕХИМИИ ИНСТИТУТА ФИЗИКО-ОРГАНИЧЕСКОЙ ХИМИИ И УГЛЕХИМИИ В монографии рассмотрены основные методические вопросы экономики развития и размещения нефтеперерабатывающей промышленности. Показаны основные пути научно-технического прогресса и его влияние на экономические показатели отрасли, методические особенности определения общей и сравнительной эффективности капитальных вложений. Особое внимание уделено методическим основам определения влияния качества нефти на экономику производства нефтепродуктов и экономической оценке качественных особенностей нефтей. Раскрыты научные основы размещения нефтеперерабатывающей промышленности, дана оценка факторов, влияющих на размещение предприятий, обоснование района размещения и мощности заводов, а также оптимальной глубины переработки нефти, методические особенности определения потребности в нефтепродуктах. Для научных и инженерно-технических работников, занимающихся вопросами экономики и технологии нефтеперерабатывающей, нефтехимической и химической промышленности, а также преподавателей и студентов вузов. Ответственный редактор Я. С. Герасимчук
Document type: Книга, Монография Year / Рік видання: 1983 Place of publication / Місце видання: Киев Publisher / Видавництво: Наукова думка Author : В.Т. Скляр, В.А. Бугров., Е.И. Наумов Language / Мова: Російська Size / Кількість сторінок: 135 с. Keywords / Ключовi слова: нефтеперерабатывающая промышленность |
 |
Соединения включения и некоторые проблемы гетерогенных равновесий. К. И. Патриляк В монографии рассмотрены теоретические и экспериментальные аспекты образования и разложения соединений включения (комплексов) карбамида. Особое внимание уделено експериментально обнаруженным аномалиям в системах карбамид – парафин – комплекс: гистерезисам и автоволновым явлениям. Предложена новая фізико-химическая модель комплексов карбамида. Сформулирована гіпотеза о характере относительного изменения давления насыщенного пара над веществом в массивном виде и в виде малих кластеров. Проанализированы вытекающие из нее следствия для процессов комплексообразования, плавления и критических явлений. Обсуждены пути интенсификации процес сов карбамидной депарафинизации. Для специалистов в области соединений включения и герерогенных систем, научных и інженерно-технических работников химической, нефтехимической и нефтеперерабатывающей промышленности.
Document type: Книга, Монография Year / Рік видання: 1987 Place of publication / Місце видання: Київ Publisher / Видавництво: Накукова думка Author : К. И. Патриляк Language / Мова: Російська Size / Кількість сторінок: 164с. Keywords / Ключові слова: кластеры, соединения включения и процессы карбамидной депарафинизации УДК 536.7 |
 |
Проблема репликации ДНК и генетические манипуляции с растениями. Е. И. Черепенко, А. П. Галкин Монография посвящена центральной проблеме генетической инженерии высших растений – конструированию и использованию векторных молекул ДНК для введения в клетке генов, придающих растению нужные человеку признаки. Описаны успехи и недостатки использующихся в экспериментальной работе интегративных векторов, обезпечивающих встраивание и закрепление в геноме клетки вводимого гена. Основное внимание уделено проблеме создания векторов репликативного типа, которые способны автономно размножаться в растительной клетке, стабильно наследоваться в клеточных поколениях и эффективно экспрессироваться в тех или иных физиологических условиях. Для молекулярных биологов, генетиков, преподавателей и студентов вузов.
Document type: Книга, Монография Year / Рік видання:1987 Place of publication / Місце видання: Киев Publisher / Видавництво: Наукова думка Author : Е. И. Черепенко, А. П. Галкин Language / Мова: Російська Size / Кількість сторінок: 160с. Keywords / Ключові слова: проблемы генетической инженерии высших растений УДК 577.213 |
 |
Каталитические процессы в нефтепереработке и нефтехимии. Избранные труды. Гутыря В.С. Представлены наиболее оригинальные работы одного из ведущих ученых страны в области нефтепереработки и нефтехимии В. С. Гутиря по каталитическому крекингу и риформингу нефтяного сырья, каталитической очистки продуктов первтчной нефтепереработки, получению спиртов из газообразных продуктов пиролиза нефтяных фракций, катализу на цеолитах углеводородного сырья. Приведен очерк о жизни и научной деятельности В. С. Гутыри, указатель его печатных работ.
Document type: Книга Year / Рік видання: 1988 Publish place / Місце видання: Киев Publisher / Видавництво: Наукова думка Author : Гутыря В.С. Авторський знак: К Language / Мова: Російська Size / Кількість сторінок: 376 с. Keywords / Ключовi слова: нефтепереработка, нефтехимия УДК 665.644 + 541.128 + 661.722.22 ISBN 5-12-000231-5 |
 |
Organic catalysts coenzymes and enzymes. A. A. Yasnikov This book describes organic catalysts, coenzymes and enzymens, and their mechanisms in chemical and biochemical processes. It outlines overall aspects of the theory of organic catalysts and enzymatic catalysis, and considers the chemical mechanisms of the vital biological processes – respiration, photosynthesis, protein synthesis, nitrogen fixation, the biosynthesis of isoprenoid compounds, as well as the chemicall models of pre-biological synthesis on Earth. The book is meant for chemists and biochemists researching in homogeneous chemical catalisis and in the mechanics of biological processes.
Document type: Книга Year / Рік видання: 1988 Place of publication / Місце видання: Москва Publisher / Видавництво: Наукова думка Author : А. А. Ясников Language / Мова: Англійська Size / Кількість сторінок: 263с. Keywords / Ключові слова: Органічні каталізатори, коферменти, ферменти, кислотно-основний каталіз, нуклеофільний каталіз, іміни, семікарбазони, оксини, фотосинтез |
 |
Физико-химия диспергирующих присадок к маслам. Главати О. Л. АН УССР, Отделение нефтехимии Института физ.-орган. химии и углехимии. В монографии представлены результаты исследований автора по механизму образования осадков в двигателях внутреннего сгорания, строения, получения и действия высокощелочных детергентов и беззольных дисперсантов. Дана характеристика явлений синергизма и антагонизма присадок в композициях. Описаны разработанные автором методы выделения дисперсной фазы высокощелочных детергентов. Установлена их мицеллярная структура, определены размеры ядер мицелл, адсорбционных и адсорбционно-сольватных оболочек. Предложен механизм действия высокощелочных детергентов, заключающийся в образовании золя СаСО3, стабилизированного в метаноле (воде) ион- по-сольватными оболочками с последующей гидрофобизацией в углеводородах за счет хемосорбции поверхностно-активных анионов. Для научных и инженерно-технических работников, занимающихся проблемами создания современных присадок к моторным маслам и освоения их производства, а также преподавателей, аспирантов и студентов вузов.
Document type: Книга, Монография Year / Рік видання: 1989 Place of publication / Місце видання: Киев Publisher / Видавництво: Наукова думка Author : Главати О. Л. Language / Мова: Російська Size / Кількість сторінок: 183 с. Keywords / Ключовi слова: Моторные масла – Присадки – Физико-химические свойства УДК 66.01.66.095.5 ISBN 5-12-000742-2 |
 |
Экотехнология. Оптимизация технологии производства и природопользования. В.П. Кухарь, И.Д. Зайцев, Г.А. Сухоруков Под редакцией академика АН УССР В.П. Кухаря В монографии изложена и обоснована концепция согласованного развития производства и природопользования на основе оптимизации экологически обусловленных технологий производства, обработки и утилизации отходов. Согласно теории развивающихся систем предложена совокупность моделей и методов оптимизации этих технологий, рассмотрены способы решения сложных задач оптимизации программ развития систем очистки городских сточных вод, объектов энергетики, а также задач охраны вод бассейна реки.
Document type: Книга, Монография Year / Рік видання: 1989 Publish place / Місце видання: Киев Publisher / Видавництво: Наукова думка Author : В.П. Кухарь, И.Д. Зайцев, Г.А. Сухоруков Language / Мова: Русский Size / Кількість сторінок: 263 с. Keywords / Ключовi слова: безотходная технология, охрана окружающей среды ISBN 5-12-000755-4 |
 |
От структуры к синтезу белка. А. А. Гершкович В доступной форме рассказано о становлении и достижениях важнейшей области биоорганической химии и молекулярной биологии – химии белков и пептидов. Огромная роль белков в функционировании живых организмов, истории изучения белковых молекул, современные воззрения на связь структуры белков с их биологическими функциями; синтез белка в клетке, направленный синтез белков и полипептидов, научные задачи, которые решаются с помощью синтетических пептидов, главные направления практического использования синтетических пептидов – основные темы книги. Для широкого круга специалистов – биологов, химиков, физиков, медиков, а также всех интересующихся проблемами синтеза белковых молекул- «молекул жизни».
Document type: Книга Year / Рік видання: 1989 Place of publication / Місце видання: Київ Publisher / Видавництво: Наукова думка Author : А. А. Гершкович Language / Мова: Російська Size / Кількість сторінок: 192 с. Keywords / Ключові слова: белковые молекулы, пептиды УДК 544 ISBN 5-12-001111-Х |
 |
Эффективность производства присадок к маслам. Журба А. С., Бурлака Г. Г., Бугров В. А. Отв. ред. Фройштетер Г. Б. АН УССР, Институт биоорганической химии и нефтехимии. В монографии рассмотрены основные направления интенсификации производства присадок к смазочным маслам на базе ускорения научно-технического прогресса и повышения эффективности их применения. Установлено влияние присадок на качество минеральных масел и работу двигателей внутреннего сгорания, выявлены возможности ресурсо- и энергосбережения в производстве и применении присадок, раскрыты особенности анализа, нормирования расхода сырья, экономические преимущества строительства специализированных заводов. Показаны направления повышения эффективности производства присадок. Для специалистов в области нефтеперерабатывающей, нефтехимической и химической промышленности.
Document type: Книга, Монография Year / Рік видання: 1990 Place of publication / Місце видання: Киев Publisher / Видавництво: Наукова думка Author : Журба А. С., Бурлака Г. Г., Бугров В. А. Language / Мова: Російська Size / Кількість сторінок: 176 с. Keywords / Ключовi слова: Моторные масла – Присадки – Научно-технический прогресс УДК 665.63: 658.5.338 ISBN 5-12-001817-3 |
 |
Полиакриламид в животноводстве. Ф. Г. Фабуляк, М. Ф. Кулик, Ж. Б. Левинтон, И. Н. Величко, Л. Д. Масленникова, В. В. Химич, Т.Л. Химич. Под ред. В. П. Кухарь Монография посвящена проблеме интенсификации животноводства. Описан механизм использования синтетических азотистых веществ в организме жвачных животных, приводятся характеристика синтетических заменителей кормового протеина и эффективность разных способов их скармливания. Излагается новое направление применения полиакриламида в сочетании с мочевиной, заменителями молока, ферментными препаратами и другими целевыми добавками, обеспечивающими повышение продуктивности животных. Приведены новые результаты физико-химических исследований взаимодействия полиакриламида с мочевиной и другими добавками неорганической и органической природы, созданы научно-обоснованные подходы к их структурному капсулированию. Показана пищевая и биологическая ценность мяса и молока сельскохозяйственных животных, при откормке которых применяли полиакриламидные добавки.
Document type: Книга, Монография Year / Рік видання: 1990 Publish place / Місце видання: Киев Publisher / Видавництво: Наукова думка Author : Ф. Г. Фабуляк, М. Ф. Кулик, Ж. Б. Левинтон, И. Н. Величко, Л. Д. Масленникова, В. В. Химич, Т.Л. Химич Language / Мова: Русский Size / Кількість сторінок: 255 с. Keywords / Ключовi слова: полиакриламид, животноводство ISBN 5-12-001427-5 УДК 636.087.7 |
 |
Фотохимическое модифицирование полиолефинов. А.А.Качан, П.В.Замотаев В монографии обобщен теоретический и экспериментальный материал по фотохимическому модифицированию полиолефинов путем сшивания, привитой полимеризации и реакции в цепях, рассмотрены особенности кинетики фотоинициированного образования макрорадикалов в полимерной матрице и влияние ее на вторичные темновые процессы, обсуждены свойства фотохимически модифицированных полиолефинов и технологические возможности их применения. Приведены данные исследований радикальных процессов сшивания этих полимеров и прививки на их поверхность виниловых мономеров, инициированных термически или под действием ионизирующих излучений. Для научных и научно-технических работников, специализирующихся в области модифицирования полимеров.
Document type: Книга, Монография Year / Рік видання: 1990 Place of publication / Місце видання: Киев Publisher / Видавництво: Наукова думка Author : А.А.Качан, П.В.Замотаев Language / Мова: Російська Size / Кількість сторінок: 280 с. Keywords / Ключовi слова: модифицирование полимеров УДК 541.14+546.42 ISBN 5-12-001420-8 |
 |
Утилизация промышленных сернистых газов., Н. И. Вилесов В. Г. Большунов В монографии изложены результаты исследования и разработки процессов, способов и устройств для очистки и утилизации выбросных сернистых газов с получением элементарной серы. Значительное внимание уделяется исследованиям химических и физических аспектов технологических процессов. Характеризуются существующие технологические возможности улучшения состояния окружающей среды и оздоровления экологической обстановки в промышленных районах страны. Для работников научных и проектно-конструкторских организаций, инженерно-технологических работников металлургических, энергетической, газоперерабатывающей и химических отраслей промышленностей.
Document type: Книга, Монография Year / Рік видання:1990 Place of publication / Місце видання: Киев Publisher / Видавництво: Наукова думка Author : Н. И. Вилесов В. Г. Большунов Language / Мова: Російська Size / Кількість сторінок: 136с. Keywords / Ключові слова: аммиачный процесс, каталитический процесс, утилизация сернистых газов УДК 546.224.31 ISBN 5-12-001418-6 |
 |
Алкилирование на цеолитах. К. И. Патриляк, Ю. Н. Сидоренко, В. А. Бортышевский. АН УССР, Институт биоорганической химии и нефтехимии В монографии обобщен материал по алкилированию углеводородов олифинами и спиртами на цеолитах широкого диапазона кислотности. Ha примерах aлкилирования изопарафиновых и ароматических углеводородов олефинами предложен принципиально новый механизм реакции электрофильного замещения, согласно которому началом превращения является протонирование алкилируемого углеводорода, а ключевая стадия процесса — гидридный перенос — осуществляется льюисовском кислотном центре, формирующем в сочетании с кислотным центром Бренстеда “суперкислотный” активный центр катализатора. Проанализированы экспериментальные данные по алкилированию толуола метиловым спиртом на цеолитах типа X и У, а также высококремнеземных цеолитах ZSM. Рассмотрены различные подходы к объяснению механизма реакции. Обсуждены практические аспекты реакций алкилирования. Для научных и инженерно-технических работников в области кислотно-основного катализа, катализа на цеолитах, нефтехимического и органического синтеза.
Document type: Книга, Монография Year / Рік видання: 1991 Place of publication / Місце видання: Киев Publisher / Видавництво: Наукова думка Author : К. И. Патриляк, Ю. Н. Сидоренко, В. А. Бортышевский Авторський знак: К Language / Мова: Російська Size / Кількість сторінок : 176 с. Keywords / Ключовi слова : Углеводороды – алкилирование каталитическое, катализаторы цеолитные УДК 665.652.4:661.183.6 ISBN 5-12-002434-3 |
 |
Химия биорегуляторных процессов. В. П. Кухарь, А. И. Луйк В монографии обобщены современные сведения о клеточных трансдуцирующих сигнальных системах. Проведен анализ результатов собственных экспериментов авторов биорегуляторов. Обоснованы и развиты новые представления о биорегуляторных стереотипах, согласно которым первичным и главным критерием рациональной систематизации физиологически активных веществ может служить характер их влияния на клеточные сигнальные системы. Обсуждается проблема выявления наиболее общих признаков электронного строения веществ, физиологические эффекты которых укладываются в два ведущих стереотипа. Круг затронутых вопросов, касающихся химических основ процессов биорегуляции, авторы предлагают рассматривать как специальный раздел биоорганической химии. Для специалистов в области биоорганической и органической химии, биохимии, биофизики, молекулярной биологии и фармакологии.
Document type / Вид документа: Книга, Монография Year / Рік видання : 1991 Place of publication / Місце видання : Київ Publisher / Видавництво : Наукова думка Author / Автор : В. П. Кухарь, А. И.Луйк Language / Мова : Російська Size / Кількість сторінок : 368с. Keywords / Ключові слова : биорегуляторные процессы, тромбин, лейкотриены УДК 577.1.01 ISBN 5-12-002426-2 |
 |
Автоматизация производств смазочных материалов. А.М. Манойло, Г.И. Чередниченко, И.М. Рудович В книге приведен обширный материал по автоматизации производств смазочных материалов. Систематизированы новые способы автоматического управления и контроля, новые стредства автоматизации для производств пластичных смазок, смазочно-охлаждающих технологических средст, присадок, обобщены примеры математического моделирования и оптимизации технологических процессов в производстве смазочных материалов, приведен анализ уровня автоматизации действующих производств смазочных материалов, показаны перспективы создания автоматизированных систем управления производствами смазочных материалов.
Document type / Вид документа: Книга, Монография Year / Рік видання : 1992 Place of publication / Місце видання : Москва Publisher / Видавництво : Химия Author / Автор : А.М. Манойло, Г.И. Чередниченко, И.М. Рудович Language / Мова : Русский Size / Кількість сторінок : 312 с. Keywords / Ключовi слова : смазочные материалы УДК 621.892:65.011.56 |
 |
От структуры к синтезу белка. А. А.Гершкович Монография посвящена современным методам химического синтеза пептидов — регуляторов биохимических процессов в организме. Приводятся методики синтеза важнейших реагентов для образования пептидной связи и защиты функциональных групп аминокислот, описываются современные методы синтеза защищенных пептидов и способы их деблокирования. Рассматриваются основные методы твердофазного синтеза пептидов, а также способы конъюгации пептидов с белками. Осуществлена классификация реагентов по принципу химического строения. Кратко рассмотрены механизмы активации карбоксильной и аминогрупп и процессов, происходящих при удалении защитных групп. В таблицах представлены характеристики многочисленных производных аминокислот и полупродуктов для синтеза пептидов. Для научных работников химического и биологического профилей, а также студентов, аспирантов и преподавателей вузов. Ил. 10. Табл. 52. Библиогр.: 336—353 (537 назв.). Ответственный редактор С. Б. Серебряный Утверждено к печати ученым советом Института биоорганической химии и нефтехимии АН Украины
Document type / Вид документа: Книга, Монография Year / Рік видання : 1992 Publish place / Місце видання : Киев Publisher / Видавництво : Наукова думка Author / Автор : А. А.Гершкович Language / Мова : Русский Size / Кількість сторінок : 360 с. Keywords / Ключовi слова : химические методы синтеза пептидов ISBN 5-12-001111-Х |
 |
Металлокомплексные ингибиторы окисления. Ковтун Г. А., Моисеев И. И. В монографии представлены фундаментальные и прикладные аспекты исследований координационных соединений металлов в качестве ингибиторов радикально-цепного окисления органических соединений молекулярным кислородом. Систематизированы результаты нового направления в создании ингибиторов окисления – металлокомплексного катализа реакций обрыва цепей и разложения разветвляющих агентов окисления. Для специалистов химической, нефтехимической и нефтеперерабатывающей промышленности, а также преподавателей, аспирантов и студентов химических факультетов вузов. Ответственный редактор А.А. Григорьев.
Document type / Вид документа: Книга Year / Рік видання : 1993 Place of publication / Місце видання : Киев Publisher / Видавництво : Наукова думка Author / Автор : Ковтун Г. А., Моисеев И. И. Авторський знак: К Language / Мова : Російська Size / Кількість сторінок : 224 с. Keywords / Ключовi слова : 541.12 Хімічна механіка Cipher / Шифр / Шифр: 541 УДК 541.49 + 541.428 + 541.127 |
 |
Химия и технология металлокомплексных стабилизаторов окисления. Г. О. Ковтун, В. А. Плужников Институт биоорганической химии и нефтехимии Монография посвящена фундаментальным и прикладным аспектам исследования комплексов метал лов в качестве стабилизаторов радикально-цепного окисленияорганических соединений молекулярным кисло родом. Обобщен материал по методам синтеза и технологии промышленных металлокомплексных стабилизаторов окисления. Систематизированы результаты нового направления в создании стабилизаторов окисления – металлокомплексного катализа радикальних реакцій обрыва цепей и разложения разветвляющих агентов окисления. Для специалистов химической, нефтехимической и нефтеперерабатывающей промышленности, а также преподавателей, аспирантов и студентов старших курсов химических и химико-технологических вузов.
Document type / Вид документа: Книга, Монография Year / Рік видання : 1994 Place of publication / Місце видання : Київ Publisher / Видавництво : ИБОНХ НАН Украины Author / Автор : Г. О. Ковтун, В. А. Плужников Language / Мова : Російська Size / Кількість сторінок : 240с. Keywords / Ключові слова : методы синтеза и технологи промышленных металлокомплексных стабилизаторов окисления УДК 541.49 |
 |
Химия илидов фосфора. Колодяжный О.И. Монография посвящена химии важнейшего класса элементорганических реагентов – илидам фосфора. Рассмотрено строение илидов фосфора, их получение различными методами, физико-химические и химические свойства. Обобщены результаты многолетних исследований реакции Виттига, современная трактовка ее механизма и стереохимии. Обсуждено применение илидов фосфора для получения природных соединений и лекарственных веществ (анитбиотиков, лейкотриенов, простагландинов, феромонов) в лаборатории и промышленности. Описано использование фосфорилидов в качестве лигандов в комплексах переходных и непереходных металлов, практическое применение этих комплексов в органическом синтезе. Приведены методики получения илидов фосфора, а также синтеза с их помощью соединений различных классов. Для химиков в области органического синтеза, сотрудников научно-исследовательских институтов и заводских лабораторий, биооргаников, неоргаников, фармакологов, а также преподавателей и студентов химических вузов.
Document type / Вид документа: Книга, Монография Year / Рік видання : 1994 Publish place / Місце видання : Киев Publisher / Видавництво : Наукова думка Author / Автор : Колодяжный О.И. Language / Мова : Русский Size / Кількість сторінок : 558 с. Keywords / Ключовi слова : илиды фосфора ISBN 5-12-004187-6 |
 |
Кислоты Льюиса – стабилизаторы окисления органических соединений. Г. А. Ковтун, В. А. Плужников В монографии кратко представлены фундаментальные и прикладне аспекты оригінального направления в создании металлсодержащих стабилизаторов окисления органических соединений – катализа кислотами Льюиса реакцій обрыва цепей и разложения разветвляющих агентов окисления (гидропероксидов) с низкой вероятностью образованиясвободных радикалов в обьеме. Для специалистов химической, нефтехимической и нефтеперерабатывающей промышленнояти, а также преподавателей, аспирантов и студентов химических спеціальностей вузов.
Document type / Вид документа: Книга, Монография Year / Рік видання : 1994 Place of publication / Місце видання : Київ Publisher / Видавництво : ИБОНХ НАН Украины Author / Автор : Г. А. Ковтун, В. А. Плужников Language / Мова : Російська Size / Кількість сторінок : 132с. Keywords / Ключові слова : кислоты Льюиса, цепные реакции окисления, кинетика и механизмы катализа, карбонатионы, стерический эффект в обрыве цепей окисления, методы исследования механизма металосодержащих стабилизаторов окисления УДК 541.49 |
 |
Наукоемкие производства нефтеперерабатывающей промышленности. Г. Г. Бурлака, Я. Е. Гарун В монографии исследуются наукоемкие производства смазочных масел и присадок к ним. С учетом состояния и перспективы развития мирового рынка этих нефтепродуктов рассмотрены вопросы маркетинга и конкурентоспособности, ценообразования, технологического прогнозирования и определения перспективной потребности, оценена эффективность производства высококачественных смазочных масел и присадок. Разработаны предложения по совершенствованию этихподотраслей нефтеперерабатывающей промышленности и улучшению управления их производствами. Для научных работников, специалистов хозяйственных органов, аспирантов и студентов экономических вузов.
Document type / Вид документа: Книга, Монография Year / Рік видання : 1994 Place of publication / Місце видання : Київ Publisher / Видавництво : Наукова думка Author / Автор : Г. Г. Бурлака, Я. Е. Гарун Language / Мова : Російська Size / Кількість сторінок : 205 с. Keywords / Ключові слова : смазочные масла и присадки к ним УДК 665.63 |
 |
Наукомісткі виробництва (мастильні матеріали, присадки, каталізатори, інгібітори корозії та поверхнево-активні речовини). Г.Г. Бурлака, Я.Є. Гарун, О.Л. Главаті, Ю.А. Музичу, Н.В. Радіонова, Б.І. Бугай. Розглянуто основні ознаки, економічну і соціальну ефективність наукомісних виробництв нафтопереробної, нафтохімічної та хімічної промисловості. Для наукових та технічних працівників, підприємств, студентів вузів і технікумів, виробників та споживачів наукомісткої продукції. Відповідальний редактор член-кореспондент НАН України М.С. Герасимчук.
Document type / Вид документа: Книга Year / Рік видання : 1995 Place of publication / Місце видання : Київ Publisher / Видавництво : Манускрипт Author / Автор : Г.Г. Бурлака, Я.Є. Гарун, О.Л. Главаті, Ю.А. Музичу, Н.В. Радіонова, Б.І. Бугай. Авторський знак: К Language / Мова : Українська Size / Кількість сторінок : 172 с. Keywords / Ключовi слова : Наукомісткі виробництва ISBN 5-12-003515-9 |
 |
Аммонийно-карбонатные соединения и регуляторы роста растений в сельском хозяйстве. Сборник научных трудов. Под ред. В. П. Кухарь В сборнике приведены результаты исследований 1992-1995 гг. по изучению эффективности аммонийно-карбонатных соединений и новых регуляторов роста растений в сельском хозяйстве. Представлены данные многочисленных опытов и производственных испытаний углеаммонийных солей и комплексных препаратов на их основе в качестве экологически чистых азотных удобрений, консервантов, обогатителей и раскислителей кормов, технологического средства для хранения и переработки льносырья. Рассмотрены аспекты развития их производства, а также вопросы эколого-экономического анализа эффективности новых технологий. Для специалистов химической промышленности и сельского хозяйства в области растениеводства, кормопроизводства, животноводства и технической переработки сельскохозяйственных культур.
Document type / Вид документа: Книга, Монография Year / Рік видання : 1995 Publish place / Місце видання : Киев Publisher / Видавництво : Наукова думка Author / Автор : Под ред. В. П. Кухарь Language / Мова : Русский Size / Кількість сторінок : 235 с. Keywords / Ключовi слова : регуляторы роста растений ISBN 5-12-004802-1 |
 |
Fluorine-containing Amino Acids: Synthesis and Properties, 1st Edition. Valery P. Kukhar, Vadim A. Soloshonok. In recent years, organo-fluorine chemistry has made a marked impact on the design and synthesis of a large variety of biologically active molecules, such as steroids, carbohydrates, amines, amino acids, peptides and other natural products. Naturally occurring amino acids play a pivotal role in living systems, and therefore synthetic fluorine-containing amino acids have been of significant interest to researchers working towards the understanding and modification of physiological processes. Fluorine-containing Amino Acids: – is the first volume devoted to the synthesis and properties of fluorine-containing amino acids – pays special attention to the preparation of enantiomerically pure acids (which are essential to the modern pharmaceutical industry) – deals with a rapidly expanding field of research – has been written by experienced researchers who are responsible for many developments in the field – highlights the interdisciplinary nature of this topic Fluorine-containing Amino Acids is the only dedicated reference in this subject and will be essential for researchers in synthetic organic, peptide, natural product, and medicinal chemistry and biochemistry.
Document type / Вид документа: Книга, Монография, Books Year / Рік видання : 1995 Publish place / Місце видання : New York Publisher / Видавництво : John Wiley & Sons, Inc., Author / Автор : V. P. Kukhar’ and V. A. Soloshonok Language / Мова : Английский Size / Кількість сторінок : 422 с. Keywords / Ключовi слова : Fluorine-Containing Amino Acids ISBN 978-0-471-95203-9 |
 |
Химия ингибиторов окисления органических соединений. Г. О. Ковтун, В. А. Плужников Впервые обобщены и систематезированы результаты по механізмам действия основних клас сов ингибиторов окисления органических соединений кислородом. Показана свіязь ингибирующей эффективности этих соединений с их строением. Представлен обзор работ нового направления по созданию ингибиторов окисления – катализаторов реакцій обрыва цепей и разложения разветвляющих агентов. Кратко рассмотрены технологи производства и торгове наименования важнейших представителей ингибиторов окисления. Для специалистов химической, нефтехимической и нефтеперерабатывающей промышленности, а также преподавателей, аспирантов и студентов старших курсов химических и технологических спеціальностей вузов.
Document type / Вид документа: Книга Year / Рік видання : 1995 Place of publication / Місце видання : Київ Publisher / Видавництво : Наукова думка Author / Автор : Г. О. Ковтун, В. А. Плужников Language / Мова : Російська Size / Кількість сторінок : 296с. Keywords / Ключові слова : окисление, ингибиторы окисления, комплексы металов, механизмы ингибирования, синэргизм ингибиторов, обрыв цепей окисления, металокомплексный катализ, реакции ингибирования УДК 542.978 |
 |
Топлива и смазочные материалы для транспотных средств. О.Л.Главати, Г. Г. Бурлака, Ю. М. Тараторин, И. М. Грищенко, В. А. Юшков Национальная Академия Наук Украины Институт биоорганической химии и нефтехимии Концерн «Украгротехсервис»
Document type / Вид документа: Книга,справочник Year / Рік видання : 1997 Place of publication / Місце видання : Київ Publisher / Видавництво : «Донеччина» Author / Автор : О. Л. Главати, Г. Г. Бурлака, Ю. М. Тараторин, И. М. Грищенко, В. А. Юшков Language / Мова : Російська Size / Кількість сторінок : 337 с. Keywords / Ключові слова : переработка нефти, моторные топлива, смазочные масла, пластичне смазки УДК 662 ISBN |
 |
Металокомплексні сполуки – диригенти фотосинтезу. В. В. Суховєєв, Г.Г. Сенченко, Г.О. Ковтун У навчальному посібнику коротко та в доступній формі узагальнено основи хімії метало комплексних сполук живих організмів. Основна увага зосереджена на ролі метало комплексних сполук у процесах фотосинтезу. Навчальний посібник для спецкурсів «Металокомплексні сполуки живих організмів» та «Фізіологія та біохімія фотосинтезу», для викладачів та студентів природничих факультетів педагогічних інститутів, а також для вчителів хімії та біології шкіл, ліцеїв та гімназій із поглибленим вивченням цих дисциплін.
Document type / Вид документа: Книга, посібник Year / Рік видання : 1997 Place of publication / Місце видання : Київ Publisher / Видавництво : ИБОНХ НАН Украина Author / Автор : В. В. Суховєєв, Г. Г. Сенченко, Г. О. Ковтун Language / Мова : Українська Size / Кількість сторінок : 122 с. Keywords / Ключові слова : металокомплексні сполуки живих організмів, хлоропласти, продукти фотосинтезу УДК 541.49 |
 |
Біостимулятори росту рослин нового покоління в технологіях вирощування сільськогосподарських культур. С. П. Пономаренко, Б. М. Черемха, Л. А. Амішин, А. Г. Мацебера, Л. Л. Зіневич, Г. С. Боровикова, Н. М. Пантелусь, В. С. Марковський, М. П. Секун, Л. Д. Тищенко, В. Г. Гуцал, І. П. Браженко, В. І. Зінченко, М. Ф. Кушицький, В. І. Морозова, М. М. Назаренко, М. С. Гаврилюк, Н. Г. Артюшенко Міністерство сільського господарства і продовольства України Національна академія наук України Українська академія наук Рекомендації розглянуті й затверджені Науково-технічною радою Міністерства сільського господарства та продовольства України, протокол №3 від 18.03.97 р.
Year / Рік видання : 1997 |
 |
Структура полимерных жидких кристаллов. В. В .Цукрук, В. В. Шилов В монографии обобщены результаты структурных исследований нового класса высокомолекулярных соединений – полимерных жидких кристал лов. Рассмотрены закономерности формирования структур жидкокристаллического типа для макромолекулярних систем гребнеобразного, линейного и «гібридного» строения, вопросы применимости современных методов структурного анализа к изучению систем с пониженной размерностью параметра порядка, принципы структурной классификации полимерных жидких кристаллов, характер структурних превращений в полимерных жидких кристалах при различных внешних воздействиях. Представлены количественные характеристики структурной организации полимерных жидких кристаллов (продольные и поперечные корреляционные длины, типа мезофаз и схемы фазових превращений, варианты молекулярних упаковок и надмолекулярной организации,ориентационные и термические процессы) для 140 систем различного строения. Для научных и інженерно-технических работников в области физики и химии полимерных жидких кристаллов.
Document type / Вид документа: Книга, збірник Year / Рік видання : 1998 Place of publication / Місце видання : Київ Publisher / Видавництво : ВВП «Компас» Author / Автор : В. В .Цукрук, В. В. Шилов Language / Мова : Російська Size / Кількість сторінок : 256 с. Keywords / Ключові слова : методы исследования структуры жидкокристаллических полимеров УДК 541.64 |
 |
Проблеми сталого розвитку України. Науковий ред.-кандидат хімічних наук В. В. Волошин У другому доповненому та уточненому виданні збірника публікуються наукові доповіді провідних фахівців, присвячені проблеми переходу України на принципи сталого розвитку. Зазначені доповіді були виголошені на трьох робочих семінарах, проведених протягом 1997 року під егідою Наукової ради НАН України з проблем навколишнього середовища і сталого розвитку, а також Національного комітету України з програми ЮНЕСКО «Людина і біосфера». Вони доповнені також матеріалами розширених засідань Президії НАН України 15 квітня 1998 року з питання « Про наукові основи сталого розвитку України» та Національного комітету МАБ України від 4 червня 1998 року з питання «Про наукові основи збереження біологічного та ландшафтного різноманіття в контексті сталого розвитку України». За своїм змістом доповіді об’єднанні у три блоки, кожен з яких висвітлює конкретний важливий аспект проблеми сталого розвитку – соціально-економічний, природничий та техніко-технологічний.
Document type / Вид документа: Книга, збірка Year / Рік видання : 1998 Place of publication / Місце видання : Київ Publisher / Видавництво : Літопис Author / Автор : Науковий ред.В. В. Волошин Language / Мова : Українська Size / Кількість сторінок : 400с. Keywords / Ключові слова : важливий аспект проблеми сталого розвитку України ISBN 966-7204-03-0 |
 |
Ориентированные полипропиленовые пленки. Замотаев П. В. Клуб упаковщиков продолжает серию своих зданий о полимерных упаковочных матеріалах. Данный обзор посвящен наиболее яркому и стремительно развивающемуся представителю этих материалов – двуосноориентированному поли пропилену. Рассмотрена технология его производства и дан обзор различных типов упаковочных пленок на его основе, проиллюстрированно их использование на современном упаковочном оборудовании. Особое внимие уделено аналізу областей использования полипропиленовых пленок в упаковке и тенденціям их развития, дана оценка экологическим аспектам роста производства и потребления этогоматериала. Обзор послужит хорошей настольной книгой для специалистов пищевой и легкой промышленности, переработки сельскохозяйственной продукции, полиграфических предприятий и изготовителей пленочной упаковки.
Document type / Вид документа: Книга Year / Рік видання : 1998 Place of publication / Місце видання : Київ Publisher / Видавництво : ИАЦ «Упаковка» Author / Автор : Замотаев П. В. Language / Мова : Російська Size / Кількість сторінок : 64с. Keywords / Ключові слова : полипропиленовые пленки, технология и производство различных типов упаковочных пленок УДК 678.029.985 |
 |
Елементи регуляції в рослинництві. Під ред. В. П. Кухаря Збірка наукових праць Національна академія наук України Інститут біоорганічної хімії та нафтохімії Науково-інженерний центр «АКСО» В збірнику наведено матеріали досліджень та результати виробничих випробувань нових ефективних та екологічно безпечних вітчизняних регуляторів росту і розвитку рослин, азотно-карбонатного добрива – вуглеамонійних солей (ВАС), а також препаратів на їх основі (ВІДАКСів) при вирощуванні основних сільськогосподарських культур. Нові агрохімікати сприяють стабілізації гумусу та збереженню родючості грунтів, стимулюють процеси біологічної азотфіксації і мобілізації фосфору, забезпечують суттєвий приріст урожаю і поліпшення його якості, позитивно впливають на екологічний стан угідь. Збірник розраховано на спеціалістів агропромислового комплексу вчених- аграріїв, фахівців вузівської та галузевої науки.
Document type / Вид документа: Книга, збірник Year / Рік видання : 1998 Place of publication / Місце видання : Київ Publisher / Видавництво : ВВП «Компас» Author / Автор : Під ред. В. П. Кухаря Language / Мова : Українська Size / Кількість сторінок : 360 с. Keywords / Ключові слова : регулятори росту та їх застосування, використання вуглеамонійних солей в сільськогосподарському виробництві УДК 631.8 |
 |
Вивчення загальної хімії за модульно-рейтинговою системою: лабораторний практикум. В. В. Суховєєв, Г. Г. Сенченко, Г. О. Ковтун, В.С. Лукач, Т. П. Медвєдєва Практикум є складовою частиною навчально- методичного комплексу з вивчення загальної хімії за модульною системою із застосуванням рейтингової системи контролю знань. Посібник включає робочу програму курсу, тематичній план учбових занять та методики виконання лабораторних робіт з дисципліни. Кожна лабораторна робота закінчується переліком контрольних завдань та запитань до теми, що вивчається. У кінці кожного модулю наведені приклади контрольних вправ з вивчених тем. Для студентів нехімічних спеціальностей сільськогосподарських та технічних вузів.
Document type / Вид документа: Книга, посібник Year / Рік видання : 1998 Place of publication / Місце видання : Київ Publisher / Видавництво : ИБОНХ НАН Украина Author / Автор : В. В. Суховєєв, Г. Г. Сенченко, Г. О. Ковтун, В. С. Лукач, Т. П. Медвєдєва Language / Мова : Українська Size / Кількість сторінок : 123 с. Keywords / Ключові слова : загальна хімія, лабораторні роботи УДК 542 |
 |
Регулятори росту рослин у землеробстві. За ред. академіка АІН України А. О. Шевченка У збірнику викладено підсумки роботи науковців різних регіонів України згідно з науково-технічноюпрограмою, що затверджена наказом по Мінсільгосппроду України та Українській академіїх аграрних наук від 22.11.1995 р. № 319/114 «Про організацію науково-виробничої перевірки і впровадження нових регуляторів росту на посівах сільськогосподарських культур». Висвітлено стан та перспективи використання регуляторів росту в землеробстві, досягнення українських вчених у створенні та дослідженні цих препаратів і технологій їх застосування. Подаються рекомендації щодо впровадження регуляторів росту рослин у сільськогосподарське виробництво. Друкується за рішенням Вченої ради УДНДПТІ «Агроресурси» від 16.10.1997 р., протокол № 7.
Year / Рік видання : 1998 УДК 631.811.98 |
 |
Металокомплекси: фармакологічні властивості. В. В. Суховєєв, Г. Г. Сенченко, Г. О. Ковтун У монографії викладені загальні уявлення про метало комплексні сполуки та їх роль в обміні живих організмів, паоказана фізіологічна роль іонів металів у процесах метаболізму. Коротко узагальнені результати досліджень фармакологічних властивостей і застосування в медичній практиці метало комплексних сполук. Показана залежність фармакологічної активності метало комплексних сполук від природи центрального атому, координаційного вузла металокомплексу та концентрації. Для викладачів та студентів природних та фармацевтичних факультетів навчальних закладів різного рівня акредитації, аспірантів працівників аптек.
Document type / Вид документа: Книга, Монографія Year / Рік видання : 1999 Place of publication / Місце видання : Київ Publisher / Видавництво : ИБОНХ НАН Украина Author / Автор : В. В. Суховєєв, Г. Г. Сенченко, Г. О. Ковтун Language / Мова : Українська Size / Кількість сторінок : 203 с. Keywords / Ключові слова : метало комплексні сполуки живих організмів, фармакологія УДК 541.49 |
 |
Phosphorus Ylides: Chemistry and Application in Organic Synthesis. Oleg I. Kolodiazhnyi When Wittig first developed and described phosphorus ylides, nobody could have imagined how useful and versatile this class of compounds could be. This book provides a comprehensive and up-to-date compilation of the chemistry and applications of phosphorus ylides in organic synthesis. The ylides are discussed as reagents in the synthesis of a broad range of substances, amongst them olefins, acetylenes, cyclic and heterocyclic compounds, in such naturally occurring compounds as pheromones, steroids and carotenoids, and pharmaceutically and biologically active compounds such as antibiotics and prostaglandins. A particularly beneficial feature of this book is the 150 key experimental procedures with all the necessary data, allowing the preparation to start immediately without the need for an extremely time-consuming literature search. But should a search prove inevitable, around 2,500 references provide easy access to the primary literature. Every chemist in academia and industry working in organic, bioorganic, inorganic, and medicinal chemistry will welcome this book as an inspiration of concepts, ideas and practical syntheses.
Document type / Вид документа: Книга, Монография, Books Year / Рік видання : 1999 Publish place / Місце видання : New York; Chichester; Brisbane; Singapore: Toronto Publisher / Видавництво : Wiley-VCH: Weinheim Author / Автор : Oleg I. Kolodiazhnyi Language / Мова : Английский Size / Кількість сторінок : 380 с. Keywords / Ключовi слова : phosphorus ylides ISBN 3-527-29531-3 |
 |
Регуляторы роста растений на основе N-оксидов производных пиридина (физико-химические свойства и биологическая активность). С.Л. Пономаренко У монографії узагальнено результати експериментальних і теоретичних пошуків регуляторів росту рослин у ряді N-окислених піридинових сполук. Розглянуто вплив на їхню активність різних зовнішніх факторів, комплексоутворення з протонодонорами і кислотами Льюїса. Описано результати численних досліджень сполук на різних сільськогосподарських культурах у лабораторних та польових умовах. Для спеціалістів у галузі фізіології рослин, фізихо-хім. гетероциклічних сполук, сільського господарства. Табл. 89. іл. 49. Бібліогр. 562 назви . В монографии подытожены результаты экспериментальных и теоретических поисков регуляторов роста растений а ряду N-окисленых пиридиновых соединений Рассмотрено влияние на их активность различных внешних факторов, комплексообразования с протонодонорами и кислотами Льюиса. Описаны результаты многочисленных испытаний соединений на разных сельскохозяйственных культурах в лабораторных и полевых условиях. Для специалистов в области физиологии растений, физико-химии гетероциклических соединений, сельского хозяйства.
Document type / Вид документа: Книга, Монография Year / Рік видання : 1999 Publish place / Місце видання : Київ Publisher / Видавництво : Техніка Author / Автор : С.Л. Пономаренко Language / Мова : Українська Size / Кількість сторінок : 272 с. Keywords / Ключовi слова : регуляторы роста растений UDK / УДК / УДК: 547.82+631.811.98 |
 |
Інвестиційні проблеми нафтопереробки України. В. Г. Бурлака Національна академія наук України Інститут біоорганічної хімії та нафтохімії Монографія присвячена дослідженню перспектив розвитку нафтопереробної промисловості України. Проаналізовано ринок нафти і нафтопродуктів, ефективність використання і відтворення виробничого капіталу. Розроблені методичні положення і визначена перспективна потреба у нафті і нафтопродуктах, обґрунтовані перспективні технології нафтопереробки, розрахована потреба й умови інвестиційного забезпечення розвитку галузі. Для науковців, спеціалістів галузі, аспірантів та студентів.
Document type / Вид документа: Книга, Монографія Year / Рік видання : 1999 Place of publication / Місце видання : Київ Publisher / Видавництво : Інститут економіки НАН України Author / Автор : В. Г. Бурлака Language / Мова : Українська Size / Кількість сторінок : 164с. Keywords / Ключові слова : розвиток нафтопереробної промисловості в Україні, нафта і нафтопродукти УДК 665+49 |
 |
Ресурсосбережение в нефтехимических производствах. Сульжик Н.И., Степанов А.В. В монографии представлены научные основы эффективного использования углеводородного сырья в нефтехимических и химических производствах. Показаны основные пути и технические средства экономии сырья и энергоресурсов в производствах многотоннажных продуктов: низших олефинов (этилена и пропилена), ацетилена, аммиака, метанола и водорода. Приведены ресурсосберегающие и малоотходные технологические схемы получения указанных продуктов. Рассмотрена проблема получения нефтехимических продуктов из природного газа. Книга предназначена для научных и инженерно-технических работников химической и нефтехимической промышленности. Она может служить учебным пособием для студентов химико-технологических и теплотехнических специальностей.
Document type / Вид документа: Книга, Монография Year / Рік видання : 2000 Place of publication / Місце видання : Киев Publisher / Видавництво : Нора-принт Author / Автор : Сульжик Н.И., Степанов А.В. Авторський знак: К Language / Мова : Російська Size / Кількість сторінок : 340 с. Keywords / Ключовi слова : ресурсосбережение УДК 665.642.4:661.938 |
 |
Металовмісні лікарські препарати. В. В. Суховєєв, Г. Г. Сенченко, Г. О. Ковтун, С. О. Приплавко У довіднику коротко узагальнені металовмісні лікарські препарати, що знайшли застосування в медичній практиці. Викладені загальні уявлення про фізіологічну роль іонів металів у процесах метаболізму. Показана залежність фармакологічної активності металовмісних сполук від природи металу та лігандного оточення. Для викладачів та студентів природничих і фармацевтичних факультетів навчальних закладів різного рівня акредитації, аспірантів та працівників аптек.
Document type / Вид документа: Книга, довідник Year / Рік видання : 2000 Place of publication / Місце видання : Київ Publisher / Видавництво : ИБОНХ НАН Украина Author / Автор : В. В. Суховєєв, Г. Г. Сенченко, Г. О. Ковтун, С. О. Приплавко Language / Мова : Українська Size / Кількість сторінок : 271 с. Keywords / Ключові слова : фізіологічна роль іонів металів у процесах метаболізму, металовмісні лікарські препарати УДК 541.49 |
 |
Повышение долговечности автомобильных двигателей. Г. А. Ковтун, В. С. Пилявський В пособии рассмотрено влияние величины компресии в циліндрах на долговечность, экономичность и экологические показатели автомобильных двигателей. Приведены результаты практического применения разработанной технологи востановления и приработки двигателей внутреннего сгорания без разборки. Предназначена для автомехаников, работников автосервиса и всех, кто любит автомобіль.
Document type / Вид документа: Книга, пособие Year / Рік видання : 2001 Place of publication / Місце видання : Київ Publisher / Видавництво : ИБОНХ НАН Украина Author / Автор : Г. А. Ковтун, В. С. Пилявський Language / Мова : Російська Size / Кількість сторінок : 63 с. Keywords / Ключові слова : компрессия, екологія, экономика УДК 621.892 |
 |
Методы экстракорпоральной гемокоррекции в онкологи. Деденко И. К., Литвинюк В. А., Касымов Ш. З., Жирнов В. В., Шницер Р. И., Кулик И. В., Лукьянчук В. Д., Деденко С. И. В монографии кратко изложены современные понятия о патогенезе и структуре синдрома эндогенной интоксикации у больных злокачественными новообразованиями, обусловленной воздействием на организм опухоли, лучевого и химиотерапевтического лечения, операционной травмы, а также осложнений как опухоли, так и послеоперационных осложнений. Обоснована необходимость применения высокоэффэктивных методов (гемо-и плазмосорбция, энтеросорбция, ультрафиолетовое и лазерное облучение крови, диализные методы, гипербарическая оксигенация, аппликационная сорбция, непрямое электрохимическоеокисление крови и др.) в комплексном лечениионкологических больных при проведении оперативного, лучевого, химиотерапевтического, комплексного и комбинированного лечения. Книга рассчитана на врачей-онкологов, хирургов, анестезиологов,терапевтов и врачей других специальностей.
Document type / Вид документа: Книга, Монография Year / Рік видання : 2002 Place of publication / Місце видання : Київ Publisher / Видавництво : Нора-друк Author / Автор : Деденко И. К., Литвинюк В. А., Касымов Ш. З., Жирнов В. В., Шницер Р. И., Кулик И. В., Лукьянчук В. Д., Деденко С. И. Language / Мова :Російська Size / Кількість сторінок : 230с. Keywords / Ключові слова : понятия о патогенезе и структуре синдрома эндогенной интоксикации у больных , комплексное лечение УДК 54-051 |
 |
Вуглеамонійні солі, комплексні добрива на їх основі та регулятор росту і розвитку рослин триман-1 для сільськогосподарського виробництва та лісорозведення У збірнику рекомендацій наведені докладні регламенти застосування в рослинництві, кормо виробництві та лісорозведенні нових ефективних та екологічно безпечних агрохімікатів — регулятора росту і розвитку рослин триман-1 та комплексних агропрепаратів на основі амонійно-карбонатних сполук, які рекомендовано до використання як добрива та як засіб для консервування рослинних кормів, зменшення їх активної кислотності та збагачення кормів на азот (сирий пpoтeїн). Технології використання нових агрохімікатів розроблено за результатами наукових досліджень та виробничих випробувань, проведених Науково-іженерним центром «АКСО» НАН України у співпраці з провідними спеціалізованими науковими установами Національної академії наук України. Української академії аграрних наук, Мінагрополітики України та інших відомств. Нові агрохімікати сприяють стабілізації гумусу та збереженню родючості ґрунтів, стимулюють процеси біологічної азотфіксації та мобілізації фосфору, посилюють стійкість рослин до стресових погодних умов та фітозахворювань, забезпечують суттєвий приріст урожаю і поліпшення йoгo якості, позитивно впливають на екологічний стан угідь.
Document type / Вид документа: Книга, Монография Year / Рік видання : 2002 Publish place / Місце видання : Киев Publisher / Видавництво : ВПП «Компас» Author / Автор : Р.С.Трускавецький (голова), О.Є.Давидова, П.Г.Дульнєв, В.М.Мокринський (відп. секретар), М.М.Сторчак, В.А.Вешицький, Н.М.Мальцева, В.В.Сірик, К.К Мельник, В.П.Ященко Language / Мова : Украинский Size / Кількість сторінок : 80 с. Keywords / Ключовi слова : регуляторы роста растений, комплексные удобрения ISBN 966-95743-7-4 |
 |
«Актуальні питання органічної та елементоорганічної хімії і аспекти викладання органічної хімії у вищій школі». Відповідальний за випуск.член-кореспондент НАН України, д.х.н., професор Ковтун Г. О. Збірник містить тези доповідей Української конференції «Актуальні питання органічної та елементоорганічної хімії і аспекти викладання органічної хімії у вищій школі» (м.Ніжин, 24-26 вересня 2002 р.) Для фахівців, що працюють у галузі органічної хімії у вищій школі.
Document type / Вид документа: Книга, збірник Year / Рік видання : 2002 Place of publication / Місце видання : Ніжин Publisher / Видавництво : НДПУ імені Миколи Гоголя Author / Автор : відповідальний за випуск.член-кореспондент НАН України, д.х.н., професор Ковтун Г. О. Language / Мова : Українська Size / Кількість сторінок : 104 с. Keywords / Ключові слова : актуальні питання органічної та елементоорганічної хімії УДК 547 |
 |
Катализ. Механизмы гомогенного и гетерогенного катализа, кластерные подходы. В. В. Гончарук, Г. Л. Камалов, Г. А. Ковтун, Е. С. Рудаков, В. К. Яцимирский Обобщены основные итоги промышленного катализа, изложен прогноз его развития. Систематизированы физико-химические проблемы и результаты исследования механизмов гомогенного, гетерогенного, а также кластерного катализа. Описаны термодинамические, квантово-химические, структурные и другие эффекты. Выявлены связи между гомогенным и гетерогенным катализом, показана перспективность развития нового научного направления – катализа химических реакций кластерами металлов (безлигандными, молекулярными). Для специалистов, работающих в области промышленного катализа, научных и инженерно-технических работников, преподавателей, аспирантов, студентов химических и химико-технологических факультетов вузов.
Document type / Вид документа: Книга, Монография Year / Рік видання :2002 Place of publication / Місце видання : Киев Publisher / Видавництво : Наукова думка Author / Автор : В. В. Гончарук, Г. Л. Камалов, Г. А. Ковтун, Е. С. Рудаков, В. К. Яцимирский Language / Мова : Російська Size / Кількість сторінок : 498с. Keywords / Ключові слова : развитие катализа, кислоты Льюиса в катализе обрыва цепей окисления органических соединений УДК 541.128 |
 |
Регуляторы роста растений. Пономаренко С.П. В монографии представлены результаты экспериментальных и теоретических исследований физиологически активных веществ в ряду N-окисленных пиридиновых соединений, их комплексов с протонодонорами, кислотами Льюиса, а также композиций с природными биологически активными веществами. Указаны подходы к созданию peгyлятopoв роста растений с целью направленной регуляции их роста, развития и продуктивности. Большое внимание уделено изучению влияния на биологическую активность различных физико-химических факторов, изучению механизма физиологического действия препаратов на клеточном уровне с использованием радиоактивно-меченных по углероду соединений, изучению биологических закономерностей «доза-эффект». Освещены токсикологические и экологические аспекты при создании регуляторов роста для экологического земледелия. Описаны способы практического использования созданных регуляторов роста и технологи их применения при обработке семян и при опрыскивании вегетирующих растений в существующих агроприемах. Предназначена для агрономов и специалистов по защите растений, специалистов вузовской и отраслевой науки в области физиологии растений биотехнологии. По своему содержанию монография является расширенным и переработанным изданием ранее опубликованной книги С.П. Пономаренко Регупяторы роста растений на основе N -оксидов производных пиридина. – К.: Техника, 1999, -272с.
Document type / Вид документа: Книга, Монография Year / Рік видання : 2003 Place of publication / Місце видання : Киев Publisher / Видавництво : Институт биоорганической химии и нефтехимии НАН Украины Author / Автор : Пономаренко С.П. Language / Мова : Російська Size / Кількість сторінок : 319 с. Keywords / Ключовi слова : регуляторы роста растений УДК 547.82+631.811.98 |
 |
Компрессия и долговечность автомобильных двигателей. Г. А. Ковтун, В. С. Пилявський В пособии рассмотрено влияние величины компреси в циліндрах на долговечность, экономичность и экологические показатели поршневих автомобильных двигателей.Описан каскадный характер ухудшения технического состояния двигателя и первоочередная роль в этом процессе локального изнашивания цилиндров в их верхней части.Особое внимание уделено повышению надежности и долговечности двигателей внутреннего сгорания по разработанной авторами технологи периодического востановления цилиндров без разборки механизма. Предназначено для автомехаников, работников автосервиса и всех, кто любит автомобіль.
Document type / Вид документа: Книга, пособие Year / Рік видання : 2003 Place of publication / Місце видання : Київ Publisher / Видавництво : ИБОНХ НАН Украина Author / Автор : Г. А. Ковтун, В. С. Пилявський Language / Мова : Російська Size / Кількість сторінок : 89 с. Keywords / Ключові слова : компрессия, екологія, экономика УДК 621.892 |
 |
Справочное пособие по использованию регуляторов роста растений. С. П. Пономаренко, Л. А. Анишин, В. О. Жилкин, З. М. Грицаенко Рекомендации разработаны с участием научных работников и специалистов УкрГНИПТИ «Агроресурсы», Института биоорганической химии и нефтехимии НАН Украины, Института микробиологии и вирусологии НАН Украины, Уманской государственной академии, Винницкой, Волынской, Полтавской, Николаевской, Ивано-Франковской, Тернопольской, Черкасской, Черниговской государственных сельскохозяйственных опытных станций УААН. Рекомендации рассмотрены и утверждены Ученым Советом УкрГНИПТИ «Агроресурсы», протокол № 2 от 11.03.2001г., решением Секции производства, переработки и хранения сельскохозяйственной продукции Научно-Технического Совета МинАПК, протокол № 4 от 25.03.2001 г. В даные рекомендации внесены дополнения- результаты исследований, проведенных в 2001-2002 годах в научных учреждениях Украины, России, Германии, Китая, Израиля. Рекомендации рассмотрены на заседании Ученого Совета Института биоорганической химии и нефтехимии НАН Украины (протокол № 1 от 29.01.2003 г.) и рекомендованы к печати.
Document type / Вид документа: Пособие Year / Рік видання : 2003 Place of publication / Місце видання : Київ Publisher / Видавництво : МНТЦ «Агробиотех» Author / Автор : С. П. Пономаренко, Л. А. Анишин, В. О. Жилкин, З. М. Грицаенко Language / Мова : Російська Size / Кількість сторінок : 35с. Keywords / Ключові слова : использование регуляторов роста УДК 631.8 |
 |
Рынок нефти и нефтепродуктов на рубеже ХХІ века. Г. Г. Бурлака, В. О. Зиневич Изложены результаты исследования рыночной трансформации нефтяного сектора экономики Украины, стран СНГ и Запада. Проанализировано состояние и определены перспективы развития и пути повышения конкурентноспособности нефтеперерабатывающей промышленности Украины. Большое внимание уделено обобщению мирового опыта в области реструктуризации нефтяного сектора в странах Евросоюза и большой восьмерки. Книга рассчитана на экономистов, научных и практических работников, студентов.
Document type / Вид документа: Книга Year / Рік видання : 2003 Place of publication / Місце видання : Київ Publisher / Видавництво : ЗАО «ВИПОЛ» Author / Автор : Г. Г. Бурлака, В. О. Зиневич Language / Мова : Російська Size / Кількість сторінок : 332с. Keywords / Ключові слова : исследование рыночной трансформации нефтяного сектора экономики Украины, стран СНГ и Запада УДК 665.5 |
 |
Достижения энергетики и защита окружающей среды. Степанов А. В., Кухарь В. П. В монографии рассмотрено современное состояние мировой энергетики и ее воздействие на окружающую среду. представлены величины выбросов диоксида углерода, их влияние на усиление парникового эффекта и изменение климата. Приведены отдельные прогнозы глобального потепления в XXI веке, дана оценка различных способов очистки дымовых газов и их эффективности для условий Украины. Представлены основные достижения теплоэнергетики к началу XXI века, даны основные характеристики современных и перспективных паротурбинных, газотурбинных и комбинированных парогазовых установок. Обоснована необходимость перехода на экологически чистую технологию использования твердых топлив. Определены преимущества и недостатки различных систем теплофикации, показаны преимущества газотурбинных и парогазовых ТЭЦ. Для экологов, энергетиков, а также широкого круга технической интеллигенции. Может быть использована в качестве учебного пособия студентами экологических и энергетических специальностей высших учебных заведений.
Document type / Вид документа: Книга Year / Рік видання : 2004 Publish place / Місце видання : Киев Publisher / Видавництво : Наукова думка Author / Автор : Степанов А. В., Кухарь В. П. Language / Мова : Російська Size / Кількість сторінок : 206 с. Keywords / Ключовi слова : енергетика, энергетика UDK / УДК / УДК 621.1:621.3+669.8 |
 |
Новые елементы биорегуляции для устойчивого развития в агроэкосистемах. Под ред. В. П. Кухаря Теоретические и прикладные аспекты, применения Обобщены результаты фундаментальних исследований и опытно-производственных испытаний эффективности использования нових агрохимикатов – удобрений на основе аммонийно-карбонатных соединений и синтетических регуляторов роста растений – производных N-оксидов пиридина в сельскохозяйственном производстве и лесоразведении.Представлены научные и прикладные аспекты их воздействия на культурные растения и почвенные микроорганизмы, процессы биологической азотфиксации, нитрификации, фотосинтеза, корнеобразования, потенциальное плодородие почв.Обоснованы эколого-экономические аспекты эффективности и перспективы использования новых агрохимикатов в агроэкосистемах. Для научных работников и специалистов библогического, анрохимического и химического профиля, специалистов вузовской и отраслевой науки, преподавателей, аспирантов, студентов вузов.
Document type / Вид документа: Книга Year / Рік видання : 2004 Place of publication / Місце видання : Київ Publisher / Видавництво : Наукова думка Author / Автор : Под ред. В. П. Кухаря Language / Мова : Російська Size / Кількість сторінок : 350с. Keywords / Ключові слова : новые элементы биорегуляции УДК 665.63 |
 |
Таємничий світ молекул. Г. А.Ковтун Молекули оточують нас усюди. Що б ми не робили, що б не тримали в руках, що б не спостерігали навколо – всюди нас супроводжують різноманітні молекули речовин та їх перетворення. Ця книжка про таємничий та захоплюючий світ молекул не тільки органічної та неорганічної хімії, а й наших почуттів, взаємин, здоров’я, жіночої краси. Матеріал подано у вигляді окремих розповідей, нарисів, замальовок. Впевнені, що книга зацікавить читачів будь-якого віку. Призначена для викладачів, учителів, студентів, учнів та всіх, хто цікавиться таємницями природи, хімією.
Document type / Вид документа: Книга Year / Рік видання : 2006 Place of publication / Місце видання : Київ Publisher / Видавництво : Вид.дім «Шкіл.світ» Author / Автор : Г. А. Ковтун Language / Мова : Українська Size / Кількість сторінок : 120с. Keywords / Ключові слова : таємничий та захоплюючий світ молекул органічної та неорганічної хімії ISBN 966-8651-59-6 |
 |
Академічна еліта в Україні. Ковтун Г. О. Ніжинський державний університет імені Миколи Гоголя Посібник містить матеріали з історії хімії в Україні та короткі біографії хіміків- членів Національної академії наук України (академіків, членів-кореспондентів,іноземних членів) з часу її заснування (1918) і до наших днів (2006). Для студентів, аспірантів, викладачів, учителів шкіл і всіх тих, хто цікавиться історією хімії та її творцями – видатними й відомими хіміками в Україні.
Document type / Вид документа: Книга, посібник Year / Рік видання : 2006 Place of publication / Місце видання : Ніжин Publisher / Видавництво : НДУ ім. М. Гоголя Аuthor / Автор : Ковтун Г. О. Language / Мова : Українська Size / Кількість сторінок : 108с. Keywords / Ключові слова : історія хіміків в Україні, біографія хіміків-членів Національної академії наук України УДК 54(09) |
 |
Про хіміків. Г. О. Ковтун У науково-популярному викладі зібрано широку панораму хімії через форму розповідей , нарисів та есе про самовідданих і захоплених творців цієї чудової науки – хіміків. Книжка для хіміків, школярів, студентів, аспірантів, викладачів і всіх тих, хто цікавиться хімією та її щирими творцями у всі часи. Серед них – хіміки в Україні.
Document type / Вид документа: Книга Year / Рік видання : 2006 Place of publication / Місце видання : Київ Publisher / Видавництво : Академперіодика Author / Автор : Г. А. Ковтун Language / Мова : Українська Size / Кількість сторінок : 264с. Keywords / Ключові слова : про хіміків УДК 54-051 |
 |
Хіміки жартують. Г. О. Ковтун У цій книжці зібрані дивні історії, поради, жарти, відповіді на «актуальні» питання життя, корисні і дотепні висловлювання хіміків та про хіміків. Призначена для викладачів, учителів, студентів, учнів та всіх, хто цікавиться хімією і її творцями усіх часів, у тому числі – хіміками в Україні.
Document type / Вид документа: Книга Year / Рік видання : 2007 Place of publication / Місце видання : Київ Publisher / Видавництво : Академперіодика Author / Автор : Г. А. Ковтун Language / Мова : Українська Size / Кількість сторінок : 184с. Keywords / Ключові слова : дивні історії, поради, жарти хіміків УДК 54-051 |
 |
Садивний та насіннєвий матеріал для зеленого будівництва та лісівництва, адаптований до стресових умов довкілля. Давидова О. Є., Мокринський В. М., Вешицький В. А., Сірик В. В., Яворовський П. П. Науково-інженерний центр «АСКО» Національної академії наук України Київське комунальне об’єднання зеленого будівництва та експлуатації зелених насаджень міста «Київзеленбуд» У монографії надано інформаційно-аналітичний матеріал на основі вітчизняних та зарубіжних джерел щодо досліду інтенсивного вирощування адаптованого до стресових умов довкілля високоякісного життєздатного садивного матеріалу для зеленого будівництва та лісівництва. Наводяться дані про сучасні технології вирощування сіянців і саджанців деревних та чагарникових порід з відкритою та закритою кореневою системою, зокрема контейнеризованих рослин, крупномірних саджанців, методів та засобів підвищення приживлюваності рослин при пересаджуванні на постійне місце. Висвітлюється зарубіжний та вітчизняний досвід організації насінництва газонних трав. Особлива увага приділяється відродженню сортів газонних трав вітчизняної селекції, в тому числі роботам д.б.н. проф. О.О. Лаптєва. Викладено досвід науково-технічного супроводження Науково- інженерним центром «АСКО» НАН України роботи Міського декоративного розсадника «Теремки», ККО «Київзеленбуд» та лісорозсадників з розробки і вдосконалення методів вирощування декоративних рослин з високою приживлюваністю та елітного районованого насіння злакових газонних трав вітчизняної селекції для потреб комунальних господарств України. На всіх етапах робіт наводяться дані про використання нових екологічно безпечних високоефективних біологічно активних препаратів. Робота розрахована на спеціалістів зеленого будівництва, лісорозсадників, фірм з озеленення, викладачів, аспірантів, студентів навчальних закладів лісотехнічних спеціальностей та міського господарства.
Document type / Вид документа: Книга,Монографія Year / Рік видання : 2007 Place of publication / Місце видання : Київ Publisher / Видавництво : ВПП «КОМПАС» Author / Автор : Давидова О. Є., Мокринський В. М., Вешицький В. А., Сірик В. В., Яворовський П. П. Language / Мова : Українська Size / Кількість сторінок : 200с. Keywords / Ключові слова : садивний та насіннєвий матеріал, сучасні технології вирощування сіянців і саджанців УДК 631.8 |
 |
Гипертермия, гипергликемия и аутогемотрансфузии в комплексном лечении онкологических больных. Деденко И. К., Литвинюк В. А., Касымов Ш. З., Жирнов В. В., Шницер Р. И., Рубис И. В., Кулик И. В., Лукьянчук В. Д. В монографии изложены современные понятия о взаимоотношении опухоли и организма, механизмах развития синдрома эндогенной интоксикации у онкологических больных, а также основные причины неэффективности лечения. Показано, что комплексное использование гипертермии, гипергликемии и аутотрансфузии очищенной через сорбенты или фотомодифицированной (лазерное или ультрафиолетовое облучение) крови, плазмы способствует существенному улучшению результатов лечения. Рассчитана на врачей-онкологов, хирургов, анестезиологов, терапевтов и врачей других специальностей.
Document type / Вид документа: Книга, Монография Year / Рік видання : 2007 Place of publication / Місце видання : Київ Publisher / Видавництво : Нора-принт Author / Автор : Деденко И. К., Литвинюк В. А., Касымов Ш. З., Жирнов В. В., Шницер Р. И., Рубис И. В., Кулик И. В., Лукьянчук В. Д. Language / Мова :Російська Size / Кількість сторінок : 318с. Keywords / Ключові слова : синдром эндогенной интоксикации у онкологических больных, комплексное использование гипертермии, гипергликемии и аутотрансфузии ISBN 966-7837-21-1 |
 |
Повышение ресурса автомобильных двигателей. В. С. Пилявский, Г. А. Ковтун В пособии рассмотрено влияние величины компрессии в цилиндрах на долговечность, экономичность и экологические показатели автомобильных двигателей. Описан каскадный характер ухудшения технического состояния двигателя и первоочередная роль в этом процессе локального изнашивания цилиндров в их верхней части.Рассмотрены различные факторы, влияющие на ресурс двигателей. Особое внимание уделено повышению надежности и долговечности двигателей внутреннего сгорания с помощью разработанной авторами технологии периодического напыления на цилиндры металлополимерного покрытия без разработки механизма. Предназначено для автомехаников, работников автосервиса и всех, кто любит автомобиль.
Document type / Вид документа: Книга, пособие Year / Рік видання : 2007 Place of publication / Місце видання : Київ Publisher / Видавництво : ИБОНХ НАН Украина Author / Автор : В. С. Пилявський, Г. А. Ковтун Language / Мова : Російська Size / Кількість сторінок : 121 с. Keywords / Ключові слова : компрессия, екологія, экономика УДК 621.892 |
 |
Адаптогенні та біологічно активні речовини для рослинництва. Давидова О.Є., Вешицький В.А., Мокринський В.М., Яворовський П.П. У монографії викладемо науково-аналітичний матеріал на основі вітчизняних і зарубіжних джерел щодо досвіду застосування біологічно активних речовин для усунення або пом’якшення при вирощуванні культурних рослин негативного впливу різних стрес-факторів абіотичної (низькі та високі температури, посухи, повені, забруднення ґрунтів та інших несприятливих факторів довкілля) і біотичної (ураження патогенами) природи. Надана характеристика регуляторів росту і розвитку рослин, а також антиоксидантів як адаптогенів і стреспротекторів. Висвітлено характеристики та досвід застосування саліцилової кислоти і мікроелементів, зокрема селену, при вирощуванні рослин у стресових умовах. Робота розрахована на спеціалістів сільського господарства, зеленого будівництва, агрохіміків, наукових працівників, викладачів, аспірантів і студентів вищих навчальних закладів сільськогосподарського і агробіологічного профілю.
Document type / Вид документа: Книга, Монография Year / Рік видання : 2008 Place of publication / Місце видання : Киев Publisher / Видавництво : ВПП „Компас” Author / Автор : Давидова О.Є., Вешицький В.А., Мокринський В.М., Яворовський П.П. Language / Мова : Українська Size / Кількість сторінок : 192 с. Keywords / Ключовi слова : біологічно активні речовини для рослинництва УДК 632.11+632.112 |
 |
Pесурсосбережение и энергохимическое использование нефти. А.В. Степанов, Г А. Ковтун, Г.Г. Матусевич, Н.И. Сульжик В монографии раскрыта роль горючих ископаемых и возобновляемых источников энергии в развитии экономики и социальной сферы. Определены основные пути энергосбережения в процессах нефтепереработки и нефтехимии. Раскрыта экономическая эффективность создания энерготехнологических установок, производящих нефтепродукты и электроэнергию. Описана технология безостаточной переработки нефти путем газификации нефтяных остатоков и использования синтез-газа для генерации электроэнергии в парогазовых установках. Исследовано энергопотребление основных процессов нефтепереработки и нефтехимии, обоснованы пути снижения энергозатрат. Особое внимание уделено вопросам создания нефтеперерабатывающих энергохимических комплексов с безостаточной переработкой нефти. Сделан вывод о существенном экономическом эффекте комплексного использования нефти, способствующего многократному снижению вредных выбросов в окружающую среду. Установлены критерии устойчивого развития мировой экономики. Для химиков в области органического синтеза, сотрудников научно-исследовательских институтов и заводских лабораторий, биооргаников, неоргаников, фармакологов, а также преподавателей и студентов химических вузов.
Document type / Вид документа: Книга, Монография Year / Рік видання : 2008 Publish place / Місце видання : Киев Publisher / Видавництво : Наукова думка Author / Автор : А.В. Степанов, Г А. Ковтун, Г.Г. Матусевич, Н.И. Сульжик Language / Мова : Русский Size / Кількість сторінок : 239 с. Keywords / Ключовi слова : нефтепереработка, нефтехимия, ресурсосбережение, энергохимическое использование нефти ISBN 978-966-00-0680-5 |
 |
Мониторинг природных и техногенных сред. Материалы Всеукраинской научной конференции. Сборник содержит материалы по проблемам мониторинга природных и техногенных сред; методом и техническим средствам экологического мониторинга. Представляет интерес для научных сотрудников, преподавателей, аспирантов, студентов, а также специалистов работающих в сфере охраны окружающей природной среды.
Document type / Вид документа: Книга, збірка Year / Рік видання : 2008 Place of publication / Місце видання : Симферополь Publisher / Видавництво : ДИАЙПИ Language / Мова : Російська Size / Кількість сторінок : 310с. Keywords / Ключові слова : проблемы мониторинга природных и техногенных сред УДК 504 |
 |
Amino Acids, Peptides and Proteins in Organic Chemistry Volume 2. Mdified Amino Acids, Organocatalysis and Enzymes
Year / Рік видання :2009 Author / Автор : Andrew B. Hughes Publisher / Видавництво /: WILEY – VCH Verlag GmbH & Co. KGaA Size / Кількість сторінок : 650 с. ISBN 978-3 527-32098-1 |
 |
Биорегуляция микробно-растительных систем. Иутинская Г.А., Пономаренко С.П., Андреюк К.И. и др. Национальная академия наук Украины Институт микробиологии и вирусологии им. Д. К. Заболотного Институт биоорганической и нефтехимии Межведомственный научно-технологический центр «Агробиотех» Украинский научно-технологический центр Рекомендовано к печати Учёным советом Института микробиологии и вирусологии им. Д. К. Заболотного НАН Украины (протокол № 9 от 08 октября 2009 г.) Рецензент: академик Национальной академии аграрных наук Украины, доктор биологических наук профессор В. Ф. Патыка. Представлены основные принципы взаимоотношений между микроорганизмами и растениями, закономерности формирования микробно-растительных систем, а также специфика их функционирования в современных агроценозах. Освещены вопросы влияния регуляторов роста растений, удобрений и средств химической защиты растений на почвенные микробные ценозы и микрофлору ризосферы. Описана роль симбиотических, ассоциативных, свободноживущих диазотрофов и стрептомицетов в микробно-растительных системах. Представлены современные взгляды на природу и физиологическую активность регуляторов роста растений, их воздействие на растительную клетку и микроорганизмы, а также роль в коррекции фитогормонального статуса растений. Приведены данные углублённых исследований механизмов физиологического действия созданных на Украине регуляторов роста растений, разработаны технологии их применения в сельском хозяйстве, лесоводстве, биотехнологии. Разработана стратегия создания полифункциональных комплексных препаратов, показано их протекторное, антистрессовое, антимутагенное действие. Приведены результаты практического использования комплексных полифункциональных биопрепаратов в современных технологиях выращивания сельскохозяйственных культур. Показана экономическая эффективность и экологическая целесообразность созданных высоких технологий. Для биологов, экологов, специалистов в области почвоведения и растениеводства, преподавателей и студентов вузов биологического и сельскохозяйственного профиля.
Document type / Вид документа: Книга, Монография Year / Рік видання : 2010 Place of publication / Місце видання : Київ Publisher / Видавництво : «НІЧЛАВА» Author / Автор : Е. И. Андреюк, А. Ф. Антипчук, О. В. Бабаянц, Л. А. Белявская, И. С. Бровко, Е. В. Валагурова, А. П. Галкин, Л. А. Галкина, А. А. Гладун, З. М. Грицаенко, И. В. Драговоз, Д. Икин, Г. А. Иутинская, В. Е. Козырицкая, Л. А. Крючкова, Н. О. Леонова, Т. В. Моисеева, Л. И. Мусатенко, Т. В. Петрук, А. А. Пиндрус, С. П. Пономаренко, О. И. Терек, Л. В. Титова, В. А. Цыганкова, Ху Вень Ксю, В. К. Яворская, Н. А. Ямборко Language / Мова :: Російська Size / Кількість сторінок : 472 с. УДК 606 : 631.811.98 + 579.64 : 573.4 ISBN 978-966-669-309-2 ББК 40.4 Биорегуляция микробно-растительных систем: Монография /Под ред. Г. А. Иутинской, С. П. Пономаренко. — К.: «НІЧЛАВА», 2010. — 472 с.: Ил. |
 |
NEW PLANT GROWTH REGULATORS: basic research and technologies of application. S. P. Ponomarenko, H. O. Iutynska The monograph is intended for specialists in the field of crop farming, plant cultivation, physiology and plant protection, genetics, microbiology, biotechnology. The readers of the monograph are: Tyshchenko E. N., Doctor of Biological Sciences, sokalo V. D., Doctor of Biological Sciences.
Document type / Вид документа: Книга, Монографія Year / Рік видання : 2011 Place of publication / Місце видання : КИЇВ Publisher / Видавництво : Нічлава Author / Автор : С. П. Пономаренко, Г. А. Иутинская Language / Мова : Англійська Size / Кількість сторінок : 210 с. УДК 631 |
 |
Наукові основи регуляції стійкості деревних і газонних рослин до стресових чинників. І.П. Григорюк, П.П. Яворовський, O.І. Серга, О.Є. Давидова. У монографії з позицій системного підходу викладено власні і літературні дані стосовно регуляції систем стійкості деревних й трав’яних газонних видів рослин до урбогенних стресових чинників. Наведено адапційні реакції, які обумовлюють формування механізмів стійкості рослин до водного, високотемпературного, мінерального та сольового стресів. Показано, що регулятори росту з фітогормональною активністю і мікроелементи виявляють стимулювальний ефект на структурно-функціональні системи життєдіяльності та продуктивність рослин. Розроблено ефективні заходи з підвищення стійкості рослин до дефіциту вологи в грунті. Для біологів, екологів, працівників зеленого господарства, лісників, викладачів і студентів, широкого кола читачів.
Document type / Вид документа: Книга, Монография Year / Рік видання : 2012 Place of publication / Місце видання : Київ Publisher / Видавництво : ТОВ «Аграр Медіа Груп» Author / Автор : І.П. Григорюк, П.П. Яворовський, O.І. Серга, О.Є. Давидова. Language / Мова : Українська Size / Кількість сторінок : 310 с. Keywords / Ключовi слова : рослини, стресові чинники УДК 630.233 : 630.182 (477.42.45.46.63) |
 |
Введення в екологічну біотехнологію. В. В. Жирнов, К. О. Чеботько, С. І. Скляр, Д. А. Савченко У навчальному посібнику приведені основні джерела антропогенних забруднень і їх класифікація. Охарактеризовані шляхи абіотичної і біологічної трансформації полютантів. Розглянуті основні закономірності біотрансформації біомаси і органічних ксенобіотиків мікроорганізмами-деструкорами. Викладені сучасні біологічні технології, що використовуються для переробки відходів,а також моніторингу забрудненості навколишнього середовища і її очищення від техногенних забруднень. Посібник призначений для студентів, що навчаються за фахом «Біотехнологія», а також для викладачів коледжів, вузів і фахівців в області охорони навколишнього середовища.
Document type / Вид документа: Книга, посібник Year / Рік видання : 2012 Place of publication / Місце видання : Київ Publisher / Видавництво : Фітосоціоцентр Author / Автор : В. В. Жирнов, К. О. Чеботько, С. І. Скляр, Д. А. Савченко Language / Мова : Українська Size / Кількість сторінок : 195 с. Keywords / Ключові слова : навколишнє середовище,екологічні проблеми, біологічне очищення стічних вод, біоочистка газоповітряних викидів, біодеградація УДК 631.812.1 |
 |
Проблемы безопасности атомной энергетики. Уроки Чернобыля: монография Б. С. Пристер, А. А. Ключников, В. М. Шестопалов, В. П. Кухарь; под ред. Б. С. Пристера Рассмотрены проблемы безопасности атомной энергетики как сложной системы, надежность которой определяется не только конструкцией и качеством основных систем и квалификацией персонала, но прежде всего соблюдением принципа приоритета безопасности над экономическими, политическими и другими факторами. Несоблюдение этого принципа стало реальной причиной ряда аварий в мировой атомной энергетике, сопровождавшихся выбросом радионуклидов в окружающую среду. Уроки Чернобыля остаются неусвоенными, что подтвердила авария на АЭС Фукусима-1 в Японии. Наиболее важный урок – постоянная готовность реагировать на аварию, чтобы защитить население не только от радиации, но и от психологического стресса. Для специалистов в области ядерной и радиационной безопасности, радиобиологии, экологии, охраны окружающей среды, сельского хозяйства, аспирантов и студентов вузов.
Document type / Вид документа: Книга, Монография Year / Рік видання : 2013 Place of publication / Місце видання : Чернобыль 2013 Publisher / Видавництво : Институт проблем безопасности АЭС НАНУ Author / Автор : Б. С. Пристер, А. А. Ключников, В. М. Шестопалов, В. П. Кухарь Language / Мова : Російська Size / Кількість сторінок : 200 с. Keywords / Ключовi слова : безопасность атомной энергетики УДК 621.039.58 |
 |
Використання регуляторів росту на рослинах помідора у зимових теплицях. І .Л. Гаврись, В. А. Циганкова, С. П. Пономаренко Представлено оцінку ефективності дії регуляторів росту рослин на ріст, розвиток, урожайність та якість прлодів помідора в умовах зимових гідропонних теплиць. Встановлено оптимальні концентрації регуляторів росту для використання їх методом передпосівного замочування насіння, обприскування розсади і вегетуючих рослин.Доведено позитивну дію регуляторів росту на якість розсади. Виявлено їх вплив на проходження початкових етапів органогенезу, активність ферментів у листах. Ріст і розвиток рослин. Для овочівників, фізіологів рослин, спеціалістів закритого грунту, студентів та аспірантів вищих навчальних закладів.
Document type / Вид документа: Книга Year / Рік видання : 2013 Place of publication / Місце видання : Вінниця Publisher / Видавництво : ТОВ «Нілан-ЛТД» Author / Автор : І. Л. Гаврись, В. А. Циганкова, С. П. Пономаренко Language / Мова : Українська Size / Кількість сторінок : 174 с. Keywords / Ключові слова : регулятори росту у зимових теплицях УДК 631.811 |
 |
Інтенсифікація технологічних процесів комплексного очищення стічних вод промислово-урбаністичних центрів. Мєшкова-Клименко Н.А., Епоян С. М., Гомеля М.Д., Нездоймінова В.І., Чернишев В .М., Кашковський В. І., Кавіцька А. О., Смолій С. К., Євдокименко В. О. Національна академія наук України Інститут колоїдної хімії та хімії води ім. А. В. Думанського Книга присвячена вирішенню актуальної науково-технічної проблеми створення і впровадження комплексних технологій очищення стічних вод промислово-урбаністичних центрів для зниження навантаження на довкілля, суттєвого зменшення забору свіжої води і сприяння сталому розвитку водних екосистем. Наведено наукові засади створення замкнених систем водокористування, в основу яких покладено ідеї раціонального використання природного біологічного потенціалу водних систем, зменшення кількості хімічних реагентів в процесах очищення, кондиціонування і утилізації відходів водоочищення. Запропоновано методологію математичного моделювання для оптимізації процесів біологічного очищення стічних вод. Теоретично обгрунтовані нові методи мембранного фільтрування, сорбції, зневоднення високовологоємних осадів. Представлено нові технології, нові конструкції очисних споруд для очищення стічних вод поверхнево-активних речовин, нафтопродуктів, іонів важких і кольорових металів, зневоднення осадів. Розроблена нова технологія одержання ефективних вуглецевих сорбентів з антрацидів Донецького басейну. Технології впроваджено на очисних спорудах ряду міст України. Книга розрахована на широке коло спеціалістів та організацій, що займаються розробкою методів охорони довкілля і очищення вод.
Document type / Вид документа: Книга Year / Рік видання : 2013 Place of publication / Місце видання : Київ Publisher / Видавництво : ТОВ « ТО Ексклюзив» Author / Автор : Мєшкова-Клименко Н.А., Епоян С. М., Гомеля М.Д., Нездоймінова В.І., Чернишев В .М., Кашковський В. І., Кавіцька А. О., Смолій С. К., Євдокименко В. О. Language / Мова : Українська Size / Кількість сторінок : 207 с. Keywords / Ключові слова : технологія очищення стічних вод УДК 628.3 |
 |
Производные 3-тиолен-1,1-диоксида. Технология, опыт применения, перспективы. Под редакцией профессора Л.Н. Шкарапуты. НАЦИОНАЛЬНАЯ АКАДЕМИЯ НАУК УКРАИНЫ ИНСТИТУТ БИООРГАНИЧЕСКОЙ ХИМИИ И НЕФТЕХИМИИ НАЦИОНАЛЬНЫЙ МЕДИЦИНСКИЙ УНИВЕРСИТЕТ имени А.А. БОГОМОЛЬЦА МЗ УКРАИНЫ В монографии обобщены результаты многолетних исследований авторов по кинетике, термохимии и теплофизике важнейших процессов получения производных 3-тиолен-1,1-диоксида, определены оптимальные условия их производства, разработаны технологические процессы и инженерные методы расчета определяющих стадий. Авторами выявлены и количественно описаны закономерности процессов электрофильного присоединения хлора к олефинам в воде и аминов к сероуглероду в этаноле, разработаны общие основы технологии процессов хлоргидринирования и дитиокарбаминирования в этаноле, решены вопросы промышленного производства, зарегистрированы и внедрены в практику высокоэффективные отечественные препараты – протравитель семян Сульфо- карбатион-К и лекарственное средство для борьбы с микозами кожи Теобон- дитиомикоцид. Для специалистов, аспирантов, преподавателей и научных сотрудников в области разработки научных основ промышленного производства продуктов органического синтеза, химических средств зашиты растений, дерматовенерологов и врачей смежных специальностей.
Document type / Вид документа: Книга, Монография Year / Рік видання : 2014 Place of publication / Місце видання : Киев Publisher / Видавництво : Наукова думка Author / Автор : Л.Н. Шкарапута. Н.Н. Доля. В.И. Степаненко, Л.М. Сасинович, Р.Ф. Пшеничук. Л.А. Тишенко, Я.В. Цехмистер, Л.Г. Яковишин Language / Мова :: Російська Size / Кількість сторінок : 608 с. УДК 66.011 + 632.95 + 616.5 |
 |
Екологічна Біотехнологія. В. В.Жирнов, Д. А. Савченко, В. С. Таргоня, Ю. В. Коломієць У навчальному посібнику приведені основні джерела антропогенних забруднень і їх класифікаціїя. Охарактеризовані шляхи абіотичної і біологічної трансформації полютантів.Розглянуті основні закономірності біотрансформації біомаси і органічних ксенобіотиків мікроорганізмами-деструкорами. Викладені сучасні біологічні технології, що використовуються для переробки відходів, а також моніторингу забрудненості навколишнього середовища і її очищення від техногенних забруднень. Посібник призначений для студентів, що навчаються за напрямом «Біотехнологія», а також для викладачів коледжів, вузів і фахівців в області охорони навколишнього середовища.
Document type / Вид документа: Книга, посібник Year / Рік видання : 2014 Place of publication / Місце видання : Київ Publisher / Видавництво : НУБіП Україна Author / Автор : В. В.Жирнов, Д. А. Савченко, В. С. Таргоня, Ю. В. Коломієць Language / Мова : Українська Size / Кількість сторінок : 235с. Keywords / Ключові слова : абіотична і біологічна трансформація, сучасні біологічні технології УДК 631.812.1 |
 |
Екологічна Біотехнологія. В. В.Жирнов, Д. А. Савченко, В. С. Таргоня, Ю. В. Коломієць У навчальному посібнику приведені основні джерела антропогенних забруднень і їх класифікаціїя. Охарактеризовані шляхи абіотичної і біологічної трансформації полютантів.Розглянуті основні закономірності біотрансформації біомаси і органічних ксенобіотиків мікроорганізмами-деструкорами. Викладені сучасні біологічні технології, що використовуються для переробки відходів, а також моніторингу забрудненості навколишнього середовища і її очищення від техногенних забруднень. Посібник призначений для студентів, що навчаються за напрямом «Біотехнологія», а також для викладачів коледжів, вузів і фахівців в області охорони навколишнього середовища.
Document type / Вид документа: Книга, посібник Year / Рік видання : 2014 Place of publication / Місце видання : Київ Publisher / Видавництво : НУБіП Україна Author / Автор / Авто: В. В.Жирнов, Д. А. Савченко, В. С. Таргоня, Ю. В. Коломієць Language / Мова : Українська Size / Кількість сторінок : 235с. Keywords / Ключові слова : абіотична і біологічна трансформація, сучасні біологічні технології УДК 631.812.1 |
 |
Phosphorus Chemistry I. Asymmetric Synthesis and Bioactive Compounds
Document type / Вид документа: Книга, Монография, Books Author / Автор : N. Bakalara • V. Dive • D. Georgiadis • O.I. Kolodiazhnyi • J.-L. Pirat • D. Virieux • J.-N. Voile • A.J. Wiemer •D.F. Wiemer Publisher / Видавництво : Topics in Current Chemistry Language / Мова : Английский Year / Рік видання : 2015 Size / Кількість сторінок : 237 с. ISBN 978-3-319-15473-2 |
 |
Asymmetric synthesis in organophosphorus chemistry. Synthetic Methods, Catalysis, and Applications. Oleg I. Kolodiazhnyi
Document type / Вид документа: Книга, Монография, Books Year / Рік видання :2016 Author / Автор : Oleg I. Kolodiazhnyi Language / Мова : Английский Publisher / Видавництво : WILEY – VCH : Weinheim Size / Кількість сторінок : 369 с. ISBN 978-3 527-34157-2 |
 |
Стереоселективный синтез фосфорорганических соединений. О.И. Колодяжный, А.О. Колодяжная Монография посвящена важной проблеме современной химии – стереоселективным методам синтеза и асимметрическому синтезу хиральных фосфорорганических соединений, а также их применению в научных исследованиях и промышленности. В книге обобщены результаты собственных исследований авторов и наиболее важные достижения мировой науки в области синтеза и практического использования хиральных фосфорорганических соединений. Детально описаны методы применения асимметрического металлоорганического, био- и органокатализа в органическом синтезе. Хиральные соединения фосфора играют важную роль во многих областях науки и промышленности. Описан синтез оптически активных природных и биологически активных соединений ( антибиотиков, простагландинов, феромонов и др.). Для химиков-органиков, специалистов, аспирантов, преподавателей, студентов, сотрудников научно-исследовательских лабораторий, биооргаников, неоргаников, фармакологов, агрохимиков. Монографія присвячена важливій проблемі сучасної хімії – стерео селективним методам синтезу та асиметричному синтезу хоральних фосфорорганічних сполук, а також їх застосуванню в наукових дослідженнях і промисловості. У книзі узагальнено результати власних досліджень авторів і найважливіші досягнення світової науки у сфері синтезу й практичного використання хоральних фосфорорганічних сполук. Детально описано методи застосування асиметричного металоорганічного, біо- та органокаталізу в органічному синтезі. Хіральні сполуки фосфору відіграють важливу роль у багатьох галузях науки і промисловості. Описано синтез оптично активних природних і біологічно активних сполук (антибіотиків, простагландинів, феромонів та ін.). Для хіміків- органіків, фахівців, аспірантів, викладачів, студентів, співробітників науково-дослідних лабораторій, біоорганіків, не органіків, фармакологів, агрохіміків.
Document type / Вид документа: Книга, Монография Year / Рік видання : 2017 Place of publication / Місце видання : Київ Publisher / Видавництво : Наукова думка Author / Автор / Автор: О.И. Колодяжный, А. О. Колодяжная Language / Мова : Російська УДК 547.241 |
 |
Біоконверсія відходів Частина I. В.В. Жирнов, Д.А. Савченко У підручнику приведені основні джерела антропогенних забруднень і їх класифікація. Охарактеризовані шляхи абіотичної і біологічної трансформації полютантів. Розглянуті основні закономірності біотрансформації біомаси і органічних ксенобіотиків мікроорганізмами-деструкорами. Викладені сучасні біологічні технології, що використовуються для переробки відходів, а також моніторингу забрудненості навколишнього середовища і її очищення від техногенних забруднень. Підручник призначений для студентів, що навчаються за спеціальністю – 162 «Біотехнології та біоінженерія», а також для викладачів коледжів, вузів і фахівців в області охорони навколишнього середовища.
Document type / Вид документа: Книга Year / Рік видання : 2017 Place of publication / Місце видання : Київ Publisher / Видавництво : ДДП «Експо-Друк» Author / Автор : В.В. Жирнов, Д.А. Савченко Language / Мова : Українська Size / Кількість сторінок : 302 с. УДК 504.062.2 |
 |
Брасиностероїди у регуляції метаболізму рослин. В.С. Кравець, М.В. Дерев’янчук, В.О. Хрипач На сучасному рівні висвітлено схему рецепції та сигналізації за дії брасиностероїдів в клітинах рослин. Викладено уявлення щодо участі фосфоліпідної сигналізації у гормональній регуляції метаболізму рослин. Описано шляхи формування фосфатидної кислоти та її участь в сигнальних мережах клітин різного рівня організації. Проведено аналіз впливу екзогенних натуральних і хімічно модифікованих брасино-стероїдів на ріст і рослин. Для наукових співробітників, аспірантів та студентів старших курсів біологічних факультетів.
Document type / Вид документа: Книга. Монографія Year / Рік видання : 2017 Place of publication / Місце видання : Луцьк Publisher / Видавництво : Терен Author / Автор : В.С. Кравець, М.В. Древ’янчук, В.О. Хрипач Language / Мова : Українська Size / Кількість сторінок : 212 с. УДК 577.175.14;577.125.53 |
 |
Advances and Trends in Biotechnology and Genetics Vol. 3. Tsygankova Victoria Anatolyivna; Lanzhuang Che; Palaniappan Ramasamy; Aruna Sharmili; Iwuagwu, Christian C.; N. J. Okonkwo et al. This book covers all areas of biotechnology, genetics and other related fields. The contributions by the authors include biosurfactants; antimicrobial activity; bio-preservation; shelf life; plasmid; algal plasmid; plasmid like DNA; fungal contamination; mycotoxins; Detarium microcarpum; Brachystegia eurycoma; Huanglongbing disease; Candidatus liberibacter asiaticus; citrus; Jatropha curcas; euphorbiaceae; essential oil; palmitic acid; linoleic acid; alloisolongifolene; ?-farnesene; moisture barrier; shelf-life of horticultural produce; SGOT; SGPT; alloxan monohydrate; aspirin; membrane stabilization; cellulase activity; actinomycetes; fermentation; carboxymethyl cellulose; xylanolytic activity; Trametes sp.; Annona senegalensis; Oulotricha subspecies; thermophiles; bacterial isolates; antibiotic resistance; pathogenicity; urinary tract infections; Dental Pulp Stem Cells (DPSC); Bone Morphogenic Protein (BMP-2) etc. This book contains various materials suitable for students, researchers and academicians in the field of biotechnology and genetics. Key words: Biotechnology, Genetics
Document type / Вид документа: Книга. Монографія Year / Рік видання : 2019 Place of publication / Місце видання : London, W1B 3HH, UK; Hooghly, West Bengal, India. Publisher / Видавництво : Book Publisher International, SCIENCEDOMAIN international Ltd. Author / Автор : Dr. Tsygankova Victoria Anatolyivna, Prof. Dr. Lanzhuang Che, Palaniappan Ramasamy; Aruna Sharmili; Iwuagwu, Christian C.; N. J. Okonkwo et al. Language / Мова : English Size / Кількість сторінок : 166 p. DOI 10.9734/bpi/atbg/v3 |
 |
Стратегія синтезу і біоактивність органічних молекул / За ред. А.І. Вовка
У монографії розглянуто актуальні проблеми синтезу, реакційної здатності і біологічної активності органічних та елементоорганічних сполук. Вона об’єднує низку доповідей, представлених на I Українській конференції «Кухарівські хімічні читання», яка була проведена в 2019 р. в Інституті біоорганічної хімії та нафтохімії ім. В.П. Кухаря НАН України. Особливу увагу приділено розвитку наукових досліджень у світлі зазначеної тематики, що виконувалась в Інституті впродовж останніх десятиліть. Розглянуто питання синтезу елементоорганічних міметиків природних сполук, хіральних фосфороорганічних аналогів природних і синтетичних речовин, макроциклів, фторовмісних будівельних блоків, фосфорильованих пептидоміметиків, модифікованих флавоноїдів. Представлено результати вивчення фосфороорганічних інгібіторів фосфатаз. Document type / Вид документа: Книга. Монографія Year / Рік видання : 2019 Place of publication / Місце видання : Київ Publisher / Видавництво : ТОВ «НВП «Інтерсервіс» Author / Автор : За ред. АІ Вовка Language / Мова : Українська, англійська Size / Кількість сторінок : 268 ISBN: 978-617-696-907-5 |
 |
The Monograph “Plant protection and bioregulation in modern agriculture”. Iutynska G.O., Biliavska L.O., Babych O.A., Tsygankova V.A., Babych A.G. The results of scientific fundamental researches of the biosynthetic ability of soil streptomycetes and their role in the formation and functioning of microbial-plant systems are presented. The new ecologically safe bioformulations with a various positive action on plant (stimulating, protective and antistress) have been created. The data about the composition of the new biological products, mechanisms of their action on plants are shown. The results of molecular genetic study proved that the mechanism of the bioformulation’s action involves gene expression through partial plant cell genome reprogramming. Its effect on plant genome was revealed in changes of populations of cytoplasmatic mRNA by induction of synthesis of small regulatory si/miRNA. with immune-protective, antiparasitic and antipathogenic properties. The results of the bioformulations testing, which confirm their effectiveness for increasing the plant resistance to phytonematodes, productivity, quality of agricultural crops and improving the ecological state of agrocenoses are confirmed. The monograph is intended for scientists of biological and agricultural profiles, as well as specialists working in the agricultural sector.
Document type / Вид документа: Книга. Монографія Year / Рік видання : 2019 Place of publication / Місце видання : Warszawa. Poland Publisher / Видавництво : Diamond trading tour Author / Автор : Iutynska G.O., Biliavska L.O., Babych O.A., Tsygankova V.A., Babych A.G. Language / Мова : English Size / Кількість сторінок : 100. ISBN: 978-83-66030-73-2 |
 |
Research Advances in Plant Biotechnology”. Series: Plant Science Research and Practices / Ed. Yaroslav B. Blume. Chapter 6. Using Microbial Biostimulants to Deliver RNA Interference in Plants as an Effective Tool for Biocontrol of Pathogenic Fungi, Parasitic Nematodes and Insects. Victoria A. Tsygankova, Konstantin B. Blyuss, Elena N. Shysha, Lyudmila A. Biliavska, Galina A. Iutynska, Yaroslav V. Andrusevich, Sergey P. Ponomarenko, Alla I. Yemets and Yaroslav B. Blume.
In Research Advances in Plant Biotechnology the potential of high technological approaches in plant genetic engineering as well as their practical applications are considered. The efficiency of plant genetic transformation remains a challenge due to limitations of intracellular transportation of genes and other biomolecules through the cell wall, damaging of cells/tissues, gene disruption, and high-cost of application of the transformation methods. From stable interest to the development of new techniques for gene delivery into plant cells, key achievements of carbon nanotubes (CNTs) and fullerene derivatives to serve as vehicles for the delivery of genetic material into plant cells and plastids are discussed. Besides CNTs and fullerenes, the mineral nanoparticles (mesoporous silica NPs, metal oxide, calcium phosphate), and cationic polymers have been proposed also for plant transformation. In the monograph, the results of practical development of efficient gene transfer techniques based on using these nanomaterials and applicable for plants are presented, too. Then the multiple strategies of site-specific recombinases application in plant genetic engineering with outlining of prospective directions of growth for this molecular tool are detailed. Currently, the CRISPR/Cas system is a powerful method for editing the genome of various organisms. The achievements and prospects of CRISPR/Cas usage for genome editing of fungi are considered in a separate chapter. Because salinity is one of major problems for modern agriculture around the world and creation of salt tolerant cultivars via conventional breeding cannot keep the pace with continuously rising food demand, one contribution to the book critically evaluates the possible roles or capacities of genes from different functional groups to improve plant salt tolerance via genetic engineering. Another chapter presents the results of systematic studies of the effects of new ecologically friendly polycomponent biostimulants of microbiological origin (developed in Ukraine on the basis of either 2,6-dimethylpyridine-N-oxide, or metabolic products of root endophyte fungus from the roots of ginseng, or metabolites of several strains of soil Streptomyces) on improving commercially useful traits in important agricultural crops, including improved growth, productivity and increased resistance to pathogenic fungi, parasitic nematodes and insects. Special attention is paid to the analysis of molecular-genetic mechanisms of the effect of microbial biostimulants at organismal, cellular, and molecular levels. The results of these studies proved that the mechanism of bioprotective effect of microbial biostimulants involves the delivery of RNA interference (RNAi) into plant cells, i.e. induction of synthesis of endogenous small regulatory si/miRNAs with immuno-protective, antipathogenic and antiparasitic properties. In the final chapter, the legal approaches to the regulation of plants produced through new breeding techniques such as gene editing are considered. Key words: Biotechnology, Biology, Life Sciences Document type / Вид документа: Книга. Монографія Year / Рік видання : 2020 Place of publication / Місце видання : USA Publisher / Видавництво : Nova Science Publishers, Inc. Author / Автор : Victoria A. Tsygankova, Konstantin B. Blyuss, Elena N. Shysha, Lyudmila A. Biliavska, Galina A. Iutynska, Yaroslav V. Andrusevich, Sergey P. Ponomarenko, Alla I. Yemets and Yaroslav B. Blume. Language / Мова : English Size / Кількість сторінок : 270. ISBN: 978-1-53616-432-9 https://novapublishers.com/shop/research-advances-in-plant-biotechnology/ |
 |
Біоактивні сполуки, нові речовини і матеріали / За загальною ред. А.І. Вовка.
У книзі представлено роботи співробітників Інституту біоорганічної хімії та нафтохімії ім. В.П. Кухаря НАН України, а також науковців інших інститутів та університетів за матеріалами ХХХV Наукової конференції з біоорганічної хімії та нафтохімії (23 квітня 2020 р., м. Київ). Виклад наукових статей об’єднано в два розділи, що присвячені синтезу і дослідженню біоактивних сполук, а також вивченню нових речовин і матеріалів та їх застосуванню. У першому розділі обговорюються питання структури, реакційної здатності і біологічної активності органічних сполук. Окрему увагу приділено in silico моделюванню властивостей потенційно біоактивних сполук, в тому числі інгібіторів терапевтично важливих ферментів, та з’ясуванню механізмів дії синтетичних і природних біорегуляторів. У другому розділі представлено результати дослідження і наукових розробок паливних і мастильних матеріалів, полімерних та інших структур. Книга розрахована на широке коло фахівців у галузі біоорганічної хімії, органічної хімії, нафтохімії, хімії високомолекулярних сполук, а також аспірантів і студентів. Рецензенти Доктор хімічних наук, професор О.А. Пуд Доктор медичних наук В.В. Жирнов Key words: органічна хімія, біоорганічна хімія, синтез, біоактивні сполуки, Document type / Вид документа: Книга. Монографія Year / Рік видання : 2020 Place of publication / Місце видання : Київ Publisher / Видавництво : ТОВ «НВП «Інтерсервіс» Author / Автор : за загальною ред. А.І. Вовка. Language / Мова : Українська Size / Кількість сторінок : 258 ISBN: 978-966-999-048-8 |
 |
Adekunle Odunayo Adejuwon and Victoria Anatolyivna Tsygankova. Chapter 3. α-Amylase Production by Toxigenic Strains of Aspergillus and Penicillium. Pp. 1-22. In Monograph “Aflatoxin B1 Occurrence, Detection and Toxicological Effects” / Ed. by Xi-Dai Long Preface. This book consists of 11 chapters, divided into four parts. The chapters are written by experts in the field of aflatoxins. Select topics are presented here to provide a snapshot of current understanding of the occurrence and metabolism of aflatoxin B1, the contamination, exposure, and detection of aflatoxin B1, and the toxicological effects and detoxification of aflatoxin. The book is intended for students and scientists working in the field of aflatoxins.
Abstract of the Chapter 3. Aflatoxins are produced by a variety of fungal species and these have contributed to devastating health problems globally. However, apart from the capability of the production of aflatoxins, the productions of enzymes by like fungi have been explored. Aflatoxin B1-producing-toxigenic strains of Aspergillus flavus (A1), Aspergillus parasiticus (A2), Penicillium citrinum (P1) and Penicillium rubrum (P2) isolated from rice were grown on a defined medium with varying carbon and nitrogen sources. They were also grown on rice as sole carbon and nitrogen source for fungal growth. In an attempt to purify, the extracellular α-amylases produced were subjected to ammonium sulfate precipitation (40–90% saturation) followed by dialysis. The aflatoxin B1-producing toxigenic strains of Aspergillus flavus (A1), Aspergillus parasiticus (A2), Penicillium citrinum (P1) and Penicillium rubrum (P2) were able to produce α-amylases in both the growth medium with varying C and N sources of fungal and also in the rice medium. The most active α-amylase activity was produced by toxigenic A. flavus (A1) with a value of 3.25 ± 0.15 Units and this was when ammonium sulfate was nitrogen source with starch as carbon source of fungal growth in the defined growth medium. These toxigenic fungal strains can be explored for the industrial production of α-amylases. Key words: α-amylase toxigenic fungi aflatoxin B1 Document type / Вид документа: Книга. Монографія Year / Рік видання : 2020 Place of publication / Місце видання : Publisher / Видавництво : IntechOpen Author / Автор : Ed. by Xi-Dai Long Language / Мова : Англійська DOI: 10.5772/intechopen.77925 |
 |
Current Research and Development in Chemistry Vol. 3 / Editor(s) Dr. Tsygankova Victoria Anatolyivna, 1st Edition
This book covers key areas of chemistry and other related fields. The contributions by the authors include thieno[2,3-b]pyridines, thieno[3,2-d]pyrimidine, [1,2,3]triazines, [1,2,4]triazines, [1,2,4]triazoles and antitumor activity, HepG-2, MCF-7, 3(5)-aminopyrazole and anticancer activity, 3,4-Diazido-5-hydroxyfuran-2(5H)-one, 3,4-diazido-5-methoxyfuran-2(5H)-one, 4,5-Diazidopyridazinones, mucobromic acid, β-Lactam, spirothiazolidinone, synthesized, cycloaddition, oxidation induction time, oxidation induction temperature, Poly(ethylene-co-propylene), ageing, microhardness, X-Ray line width, diels-Alder reaction, hexa chloro cyclopentadiene, optimum conditions, sulfate-reducing bacteria, polypropylene, material testing, Polycyclic Aromatic Hydrocarbons (PAHs), combustion, QuEChERS and contamination, multiresidue, pesticide residues, QuEChERS and GC-MS/MSTQD, chloromethane, silica-alumina, deactivation, fixed-bed reactor, hydrocarbons, osmotic coefficients, activity of water, electrolytic solution model, inorganic monoacid, alkali etc. This book contains various materials suitable for students, researchers and academicians of this area. Document type / Вид документа: Книга. Монографія Year / Рік видання : 2020 Place of publication / Місце видання :London Publisher / Видавництво : Book Publisher International Author / Автор : Editor(s) Dr. Tsygankova Victoria Anatolyivna Language / Мова : Англійська Size / Кількість сторінок : 164 |
 |
Adekunle Odunayo Adejuwon, Marina Donova, Victoria Anatolyivna Tsygankova and Olubunmi Obayemi. Chapter 10 “Characterisation of Endo-Polygalacturonases Activities of Rice (Oryza sativa) Fungal Pathogens in Nigeria, West Africa” In Monograph “Grain and Seed Proteins Functionality ” / Edited by Jose Carlos Jimenez-Lopez. Spanish National Research Council (CSIC). IntechOpen. London, UK. Published: June 30th 2021. Abstract of Book. Climate resilience and growing population are the two main global challenges that encourage the development of an affordable and sustainable source of vegetable protein to ensure future food security. Advanced scientific programs and agro-food developments should be proprietarily on-demand to face different stresses in order to maintain yield and quality of seed production. In this regard, legume crops are key sustainable alternatives for healthier diets while contributing to appropriate natural resource management. Taken together, the 11 chapters in this book represent a generous addition to the progress in our understanding of climate-resilient legumes, hoping to contribute to the improvement of global food security in the future. Abstract of Chapter 10. Key words: Rice (Oryza sativa), phytopathogen, fungimicrobial enzymes, polygalacturonase, endo-polygalacturonase purification, characterization Document type / Вид документа: Книга. Монографія Year / Рік видання : 2021 Place of publication / Місце видання : London, UK Publisher / Видавництво : IntechOpen Author / Автор : Editor Jose Carlos Jimenez-Lopez, Spanish National Research Council (CSIC) Language / Мова : English ISBN: 978-1-83968-591-0. Print ISBN: 978-1-83968-590-3. eBook (PDF) ISBN: 978-1-83968-592-7 DOI: http://dx.doi.org/10.5772/IntechOpen.94763 |
 |
Біоактивні сполуки, нові речовини і матеріали / За загальною ред. А.І. Вовка. У книзі представлено роботи співробітників Інституту біоорганічної хімії та нафтохімії ім. В.П. Кухаря НАН України, а також науковців інших інститутів та університетів за матеріалами ХХХVI Наукової конференції з біоорганічної хімії та нафтохімії (17 червня 2021 р., м. Київ). Виклад наукових статей об’єднано в два розділи, що присвячені синтезу і дослідженню біоактивних сполук, а також вивченню нових речовин і матеріалів та їх застосуванню. У першому розділі обговорюються питання структури, реакційної здатності і біологічної активності органічних сполук. Окрему увагу приділено in silico моделюванню властивостей потенційно біоактивних сполук, в тому числі інгібіторів терапевтично важливих ферментів, та з’ясуванню механізмів дії синтетичних і природних біорегуляторів. У другому розділі представлено результати дослідження і наукових розробок паливних і мастильних матеріалів, полімерних та інших структур. Книга розрахована на широке коло фахівців у галузі біоорганічної хімії, органічної хімії, нафтохімії, хімії високомолекулярних сполук, а також аспірантів і студентів Key words: органічна хімія, біоорганічна хімія, синтез, біоактивні сполуки, Document type / Вид документа: Книга. Монографія Year / Рік видання : 2021 Place of publication / Місце видання : Київ Publisher / Видавництво : ТОВ «НВП «Інтерсервіс» Author / Автор : за загальною ред. А.І. Вовка. Language / Мова : Українська Size / Кількість сторінок :184 ISBN 978-966-999-198-0 |
 |
Cинтез і біоактивність функціоналізованих азотовмісних гетероциклів / За редакцією А.І. Вовка.
У монографії розглянуто методи синтезу і деякі питання біоактивності функціоналізованих азотовмісних гетероциклічних сполук. Зокрема, обговорюється синтез нових п’яти- і шестичленних гетероциклів та їх конденсованих похідних із застосуванням хлоровмісних 2-аза-1,3-бутадієнів, синтез поліфлуороалкілвмісних піролів та алкалоїдів піролідинового ряду, синтез 7Н-піроло[2,3-d]піримідинів, піразоло[1,5-a]піразинів, спіроциклічних піримідин-2,4,6-тріонів, а також реакції О-ацилзаміщених структурних аналогів тіаміну. Окрему увагу приділено висвітленню властивостей гетероциклічних сполук в модельних системах in silico та in vitro, вивченню інгібіторів деяких терапевтично важливих ензимів, а також пошуку і створенню регуляторів росту рослин. Книга розрахована на наукових співробітників – спеціалістів у галузі біоорганічної, органічної та медичної хімії, а також викладачів вищих закладів освіти хіміко-біологічного профілю та аспірантів. Key words: органічна хімія, біоорганічна хімія, синтез, біоактивні сполуки, Document type / Вид документа: Книга. Монографія Year / Рік видання : 2021 Place of publication / Місце видання : Київ Publisher / Видавництво : ТОВ «НВП «Інтерсервіс» Author / Автор : за редакцією А.І. Вовка. Language / Мова : Українська Size / Кількість сторінок :332 ISBN 978-966-999-222-2 |
 |
Біоактивні сполуки, нові речовини і матеріали / За загальною ред. А.І. Вовка. У книзі представлено роботи співробітників Інституту біоорганічної хімії та нафтохімії ім. В.П. Кухаря НАН України, а також науковців інших інститутів та університетів за матеріалами ХХХVII наукової конференції з біоорганічної хімії та нафтохімії (16 червня 2022 р., м. Київ). Виклад наукових статей об‘єднано в два розділи, що присвячені синтезу і дослідженню біоактивних сполук, а також вивченню нових речовин і матеріалів та їх застосуванню. У першому розділі обговорюються питання синтезу, структури, реакційної здатності і біологічної активності органічних сполук. Окрему увагу приділено in silico моделюванню властивостей потенційно біоактивних сполук, вивченню механізмів дії синтетичних і природних біорегуляторів та з‘ясуванню зв‘язку між структурою і активністю нових речовин. У другому розділі представлено результати теоретичних досліджень і практичних наукових розробок, що стосуються паливних і мастильних матеріалів, каталізаторів для нафтохімії, нових полімерних композицій, потенційних сорбентів тощо. Книга розрахована на широке коло фахівців у галузі біоорганічної хімії, органічної хімії, нафтохімії, хімії високомолекулярних сполук, а також аспірантів і студентів. Key words: органічна хімія, біоорганічна хімія, синтез, біоактивні сполуки, Document type / Вид документа: Книга. Монографія Year / Рік видання : 2022 Place of publication / Місце видання : Київ Publisher / Видавництво : ТОВ «НВП «Інтерсервіс» Author / Автор : за загальною ред. А.І. Вовка. Language / Мова : Українська Size / Кількість сторінок :328 ISBN 978-966-999-285-7 |
 |
V. A. Tsygankova, Ya. V. Andrusevich, O. I. Shtompel, R. M. Solomyanny, A. O. Hurenko, M. S. Frasinyuk, G. P. Mrug, O. V. Shablykin, S. G. Pilyo, A. M. Kornienko & V. S. Brovarets (2022). New Auxin and Cytokinin Related Compounds Based on Synthetic Low Molecular Weight Heterocycles. Chapter 16. Pp. 353-377. In: Aftab, T. (eds) Auxins, Cytokinins and Gibberellins Signaling in Plants. Signaling and Communication in Plants. Springer Nature Switzerland AG. 377 p. https://doi.org/10.1007/978-3-031-05427-3_16
Abstract of Book. Plant hormones have pivotal roles in the regulation of plant growth, development, and reproduction. Their signaling pathways are interconnected in a complex network, which provides plants with an enormous regulatory potential to rapidly adapt to their environment and to utilize their limited resources for growth and survival in a cost-efficient manner. Auxin is a hormone molecule whose activity levels are most important for its regulatory roles during plant cell, organ, and tissue development. Therefore, the precise regulation of auxin levels is an essential mechanism to fine-tune the activity of this powerful hormone during plant growth and development. Likewise, cytokinins exhibit a wide range of physiological functions, including regulation of shoot and root apical meristems, stimulation of branching, vascular development, chloroplast differentiation, stabilization of the structure and function of the photosynthetic machinery, delay of senescence, stomata opening, and elevation of the sink strength and nutritional signaling. Moreover, gibberellins also regulate many aspects of plant growth and development including seed germination, stem elongation, leaf expansion, and flower and fruit development. The broad implication of gibberellins in plant development is strictly associated with tight regulation of their metabolism by multiple environmental and endogenous factors, ranging from light and temperature to other hormones including feedback control. Understanding the significant roles of these phytohormones in plant biology, the current subject has attracted the attention of scientists from across the globe. This comprehensive volume “Auxins, Cytokinins and Gibberellins Signaling in Plants” highlights the various prospects involved in the current scenario. The book comprises the chapters from diverse areas dealing with biotechnology, molecular biology, proteomics, genomics, metabolomics, etc. Key words: Auxins, Cytokinins, Gibberellins, Signaling, Phytohormones Abstract of Chapter 16. Our chapter is devoted to the biological screening of new effective substitutes of plant hormones auxins and cytokinins among synthetic low molecular weight heterocyclic compounds, derivatives of pyridine, pyrimidines, pyrazolotriazinones, oxazoles, oxazolopyrimidines and isoflavonoids. The auxin-like and cytokinin-like activity of chemical low molecular weight heterocyclic compounds, derivatives of pyridine, pyrimidine, pyrazole, isoflavones, oxazolopyrimidine and oxazole was studied. A specific bioassay on auxin-like activity showed a high stimulating effect of the chemical heterocyclic compounds, derivatives of pyridine, pyrimidine, pyrazole and isoflavones used at the concentration 10–8 M on the formation of adventitious roots on the 14th-day-old leaf petioles isolated from seedlings of haricot bean (Phaseolus vulgaris L.) cultivar Belozernaya, which was similar or higher of the effect of plant hormones auxins IAA and NAA used at the same concentration 10−8 M. A specific bioassay on cytokinin-like activity showed a high stimulating effect of the chemical heterocyclic compounds, derivatives of pyridine, pyrimidine, pyrazole, isoflavones, oxazolopyrimidine and oxazole used at the concentrations 10–8 M and 10–9 M on the growth of biomass of 16th-day-old cotyledons isolated from seeds of muscat pumpkin (Cucurbita moschata Duch. et Poir.) cultivar Gilea, which was similar or higher of the effect of plant hormone cytokinin Kinetin used at the same concentrations 10–8 M and 10–9 M. The results obtained confirmed the inducing auxin-like and cytokinin-like effect of chemical low molecular weight heterocyclic compounds, derivatives of pyridine, pyrimidine, pyrazole, isoflavones, oxazolopyrimidine and oxazole on plant cell elongation, division, and differentiation that are the basic processes of plant growth. The practical application of derivatives of pyrimidine, pyrazole, isoflavones, pyridine, oxazolopyrimidine and oxazole as new plant growth regulators was proposed. Key words: Plant hormones, IAA, NAA, Kinetin, Pyridine, Pyrimidine, Pyrazole, Isoflavones, Oxazolopyrimidine, Oxazole, Phaseolus vulgaris, Cucurbita moschata Duch. et Poir Document type / Вид документа: Книга. Монографія Year / Рік видання : 2022 Place of publication / Місце видання : Gewerbestrasse 11, 6330 Cham, Switzerland Publisher / Видавництво : Springer Nature Switzerland AG Author / Автор : Editor Dr. Tariq Aftab, Department of Botany Aligarh Muslim University Aligarh, IndiaLanguage / Мова : English Size / Кількість сторінок :377 |
 |
Edited by V. A. Tsygankova (2023). Research Advances in Microbiology and Biotechnology Vol. 3. PB International https://doi.org/10.9734/bpi/ramb/v3
Abstract of Book. his book covers key areas of Microbiology and Biotechnology. The contributions by the authors include biosafety, risk assessment, antifungal activity, biocontrol agent, polymerase chain reaction assays, DNA sequencing, molecular characteristics, bacteriophages, antimicrobial resistance, lytic phages, lysogenic phages, biofilm, amide derivatives, antimicrobial activity, disk diffusion method, molecular identification, low postharvest physiological deterioration, COVID-19, thromboembolic events, arterial thrombotic events, venous thrombotic events, bleedings, hemostasis, and anticoagulant therapy. This book contains various materials suitable for students, researchers and academicians in the field of Microbiology and Biotechnology. Document type: Книга. Монографія Year / Рік видання: 2023 Place of publication / Місце видання:India.United Kingdom Publisher / Видавництво:PB InternationalAuthor : Editor V.A. TsygankovaLanguage / Мова: English Size / Кількість сторінок:167 |
 |
Edited by V. A. Tsygankova (2023). Novel Aspects on Chemistry and Biochemistry Vol.1 PB International
Abstract of Book. This book covers key areas of chemistry and biochemistry. The contributions by the authors include heavy metals, effluents, anthropogenic activities, environmental pollution, polyaromatic hydrocarbon, adenine-guanine transition, SMD simulations, solution reaction mechanisms, genetic mutation, agricultural wastes, aquatic system, mutagenic effect, electro dialysis, reverse osmosis, electrochemical treatments, kidney dysfunction, hepatic damage, hypertension, phosphate solubilizing microbes, oxidation pathway, bioproducts, biorefinery, lignocellulosic biomass, technical lignin, flavonoids, lipid peroxidation, hydrolytic stability, thermal stability, adsorption, copper ions, agricultural waste, acetylcholine receptors, hydrolases, photo switches, diazo carbonyls, thin layer chromatography, anorexia, eating disorder, fatty acid molecules, redundant, isotherms, herbicide, and biowaste. This book contains various materials suitable for students, researchers and academicians in the field of chemistry and biochemistry. Key words: Хімія та біохімія. Chemistry and Biochemistry. Document type: Книга. Монографія Year / Рік видання: 2023 Place of publication / Місце видання:India.United Kingdom Publisher / Видавництво:PB InternationalAuthor : Dr. Tsygankova Victoria Anatolyivna. Department for Chemistry of Bioactive Nitrogen-Containing Heterocyclic Compounds, V.P. Kukhar Institute of Bioorganic Chemistry and Petrochemistry of National Academy of Sciences of Ukraine, Ukraine.Language / Мова: English Size / Кількість сторінок :179 ISBN 978-81-19217-26-7 (Print) ISBN 978-81-19217-06-9 (eBook) DOI: 10.9734/bpi/nacb/v1 |
 |
Біоактивні сполуки, нові речовини і матеріали / За загальною ред. А.І. Вовка.
У книзі представлено роботи співробітників Інституту біоорганічної хімії та нафтохімії ім. В.П. Кухаря НАН України, а також науковців інших інститутів та університетів за матеріалами ХХХVIII наукової конференції з біоорганічної хімії та нафтохімії (15 червня 2023 р., м. Київ). Наукові статті подано у двох розділах, що відображають тенденції розвитку сучасної біоорганічної хімії, органічної хімії, нафтохімії, хімії високомолекулярних сполук. Перший розділ присвячений синтезу, дослідженню структури, реакційної здатності та біологічної активності органічних сполук, а також моделюванню властивостей потенційно біоактивних сполук. Другий розділ містить результати теоретичних досліджень і практичних наукових розробок, що стосуються паливних і мастильних матеріалів, каталізаторів для нафтохімії, нових полімерних композицій та їх наповнювачів, потенційних сорбентів, а також охорони навколишнього середовища. Книга розрахована на широке коло фахівців у галузі хімії та біології, а також аспірантів і студентів. Keywords: органічна хімія, біоорганічна хімія, синтез, біоактивні сполуки, Document type / Вид документа: Книга. Монографія Year / Рік видання : 2023 Place of publication / Місце видання : Київ Publisher / Видавництво : ТОВ «НВП «Інтерсервіс» Author / Автор : за загальною ред. А.І. Вовка. Language / Мова : Українська Size / Кількість сторінок :282 ISBN 978-966-999-365-6 |
|
Research Advances in Microbiology and Biotechnology Vol. 6 Dr. Tsygankova Victoria Anatolyivna. Department for Chemistry of Bioactive Nitrogen-Containing Heterocyclic Compounds, V.P. Kukhar Institute of Bioorganic Chemistry and Petrochemistry of National Academy of Sciences of Ukraine, Ukraine.
This book covers key areas of Microbiology and Biotechnology. The contributions by the authors include biosciences, biotechnology, bioethics, catalase, purification, enzyme characterization, bacteriocins, serum cholesterol, fermentation, lactobacilli, crop production, organic, mineral compounds, endophytic fungi. This book contains various materials suitable for students, researchers and academicians in the field of Microbiology and Biotechnology. Document type / Вид документа: Книга. Монографія Year / Рік видання : 2023 Place of publication / Місце видання :India.United Kingdom Publisher / Видавництво : PB International Author / Автор : Editor(s) Dr. Tsygankova Victoria Anatolyivna. Department for Chemistry of Bioactive Nitrogen-Containing Heterocyclic Compounds, V.P. Kukhar Institute of Bioorganic Chemistry and Petrochemistry of National Academy of Sciences of Ukraine, Ukraine ISBN 978-81-19315-43-7 (Print) DOI: 10.9734/bpi/ramb/v6 |
 |
Novel Aspects on Chemistry and Biochemistry Vol. 4 Dr. Tsygankova Victoria Anatolyivna. Department for Chemistry of Bioactive Nitrogen-Containing Heterocyclic Compounds, V.P. Kukhar Institute of Bioorganic Chemistry and Petrochemistry of National Academy of Sciences of Ukraine, Ukraine.
This book covers key areas of chemistry and biochemistry. The contributions by the authors include cytogenetic methods, plant test-system, animal test-system in vivo, human lymphocytes in vitro, Pr3+-doped CdWO4 nanoparticles, fiber morphology, phenylbenzopyrone, flavonoids, anti-oxidant, anti-inflammmatory, immunomodulatory, antiviral properties, antimutagenic and anticarcinogenic properties, new schiff base complexes, pulp blending, chipping, beating, physical strength, metal complexes, anti-cancer activity, cell viability, photocatalytic, kinetic study, current photocatalytic system, metal tungstates, Scheelite, wolframite, stoichiometric amount, charge transfer molecules, molecular docking, MEP mapping and mulliken charge distribution, thermogravimetric analysis, Brunauer-Emmett-Teller (BET) analysis, carboxyl group, inflammatory proteins, acrylate-based high internal Phase emulsions, differential scanning calorimetry, chemical potential and electrophilic index. This book contains various materials suitable for students, researchers and academicians in the field of chemistry and biochemistry. Document type: Книга. Монографія Year / Рік видання : 2023 Place of publication / Місце видання :India.United Kingdom Publisher / Видавництво : PB International Author / Автор : Editor(s) Dr. Tsygankova Victoria Anatolyivna. Department for Chemistry of Bioactive Nitrogen-Containing Heterocyclic Compounds, V.P. Kukhar Institute of Bioorganic Chemistry and Petrochemistry of National Academy of Sciences of Ukraine, Ukraine ISBN 978-81-19491-04-9 (Print) DOI: 10.9734/bpi/nacb/v4 |
 |
Agricultural Research Updates. Vol. 46. Editor(s): Prathamesh Gorawala and Srushti Mandhatri. Nova Science Publishers, Inc., NY, USA.
Abstract of Chapter 1. This Chapter presents the results of laboratory studies on the impact of the ecologically friendly polycomponent microbial biostimulants on physiological and molecular-genetic characteristics of growth and development of such economically essential crops as wheat and potato along with their adaptation to the stress abiotic and biotic factors. The applied multicomponent microbial biostimulants Regoplant, Stimpo, Biosil and Radostim were developed on the basis of chemical compounds, namely: derivative of 2,6-dimethylpyridine-N-oxide and metabolic products of the fungus-endophyte of ginseng roots (Panax ginseng L.). The microbial biostimulants Avercom, Avercom nova-2, Phytovit and Violar were developed on the basis of secondary metabolites and antiparasitic macrolide and polyene antibiotics of several strains of soil actinomycetes belonging to the genus Streptomyces. These polycomponent microbial biostimulants known to be nontoxic for plants and the environment have a strong stimulating effect on plant growth and a protective effect against pathogens, pests and adverse environmental factors. The research is aimed at the use of biostimulants Avercom, Avercom nova-2, Phytovit and Violar to obtain in vitro potato lines resistant to the plant-parasitic nematode Heterodera schachtii. Attention is also paid to the results of the effect of multicomponent microbial biostimulants Regoplant, Stimpo, Biosil and Radostim on increasing the adaptation of wheat to salt stress and water deficit. The obtained results have confirmed that Avercom, Avercom nova-2, Phytovit and Violar increase the efficiency of potato plant regeneration and enhance the resistance of regenerated plants to parasitic nematode H. schachtii. The positive effect of Regoplant, Stimpo, Biosil and Radostim on the adaptation of wheat to salt stress and water deficit is illustrated. The mechanisms of the bioprotective effect of these polycomponent biostimulants are based on their direct stimulating action on plant growth and development, as well as their indirect effect on plant resistance to abiotic and biotic stresses by inducing the synthesis of endogenous small regulatory si/miRNAs involved in the RNAi process. This Chapter contains materials of theoretical and practical importance to students, researchers and academicians in the field of Microbiology, Agriculture and Biotechnology. Document type: Книга. Монографія Year / Рік видання : 2023 Place of publication / Місце видання : NY, USA Publisher / Видавництво : Nova Science Publishers, Inc. Author / Автор : Editor(s): Prathamesh Gorawala and Srushti Mandhatri. Authors of Chapter 1: V.A. Tsygankova, (V.P. Kukhar Institute of Bioorganic Chemistry and Petrochemistry of the National Academy of Sciences of Ukraine), Spivak S.I., Shysha E.N., Pastukhova N.L., Kyrylenko V.M., Yemets A.I., Blume Ya.B. (Institute of Food Biotechnology and Genomics, National Academy of Sciences of Ukraine), Biliavska L.A., Iutynska G.A. (D.K. Zabolotny Institute of Microbiology and Virology, National Academy of Sciences of Ukraine). ISBN 979-8-89113-332-7 |
 |
Research Perspectives of Microbiology and Biotechnology Vol.2. Tsygankova Victoria. PB International
Abstract. Document type: Книга. Монографія Year / Рік видання : 2024 Place of publication / Місце видання :India.United Kingdom. Publisher / Видавництво : PB International. Author / Автор : ditor(s) Dr. Tsygankova Victoria Anatolyivna. Department for Chemistry of Bioactive Nitrogen-Containing Heterocyclic Compounds, V.P. Kukhar Institute of Bioorganic Chemistry and Petrochemistry of National Academy of Sciences of Ukraine, Ukraine. ISBN 978-81-972325-7-2 (Print) ISBN 978-81-972325-0-3 (eBook) DOI 10.9734/bpi/rpmab/v2 |
 |
Біоактивні сполуки, нові речовини і матеріали / За загальною ред. А.І. Вовка
У книзі представлено роботи співробітників Інституту біоорганічної хімії та нафтохімії ім. В.П. Кухаря НАН України, а також науковців інших інститутів та університетів за матеріалами ХХХIХ наукової конференції з біоорганічної хімії та нафтохімії (30 травня 2024 р., м. Київ). Наукові статті за тематикою з біоорганічної хімії, органічної хімії, нафтохімії, хімії високомолекулярних сполук зібрано у два розділи. У першому розділі подано результати синтезу нових органічних сполук, дослідження їх реакційної здатності та біологічної активності, а також взаємозв’язку між структурою і активністю. У другому розділі представлено наукові розробки, що стосуються нових полімерних композицій різного призначення з покращеними цільовими характеристиками, паливних і мастильних матеріалів, каталізаторів олеохімічних перетворень і переробки антропогенних відходів. Книга призначена для широкого кола фахівців у галузі хімії та біології, а також аспірантів і студентів. Keywords: органічна хімія, біоорганічна хімія, синтез, біоактивні сполуки, Document type / Вид документа: Книга. Монографія Year / Рік видання : 2024 Place of publication / Місце видання : Київ Publisher / Видавництво : ТОВ «НВП «Інтерсервіс» Author / Автор : за загальною ред. А.І. Вовка. Language / Мова : Українська Size / Кількість сторінок :306 ISBN 978-966-999-459-2 |
 |
Recent Developments in Chemistry and Biochemistry Research Vol. 8 / Eds. Dr. Tsygankova Victoria Anatolyivna.
This book covers key areas of chemistry and biochemistry. The contributions by the authors include Stobbe condensation, solvent–free synthesis, green method , substituted dicarboxylic acids, nano chip system, photochromic studies, nanotechnology, quantum dot fluorescence, atomic force microscopy, biosensors, genetic sequencing, carbon nanotubes for cancer diagnosis, polymerase chain reaction, pyranoanthocyanins, anthocyanin derivatives, type A vitisins, wine aging process, antibacterial screening, benzenesulfonylation, spectroscopy, wood biochar, adsorption, heavy metal pollution, electroplating, mining operations, hypertension, lung damage, renal dysfunction, ionic exchange, adsorption, electrochemical deposition, reverse osmosis, electro-dialysis, electrochemical reduction, ultrafiltration, solvent extraction, electrical conductor, eugenol-based polymers, self-replicating smart nanorobots, polymerization of monomers, pyranoanthocyanin formation, high-performance liquid chromatography, circular dicroism, eugenol-based polyacetylenes, neurodegenerative disorders, organic water pollutants, semiconductor catalyst, Gibbs free energy, natural reductants, lawsonia inermis linn leaf, corrosion resistance, electroless nickel, anti-obesity drugs, vita slim, glycine solubility, Van’t Hoff equation. This book contains various materials suitable for students, researchers, and academicians in the fields of chemistry and biochemistry. Keywords: хімія, біохімія, chemistry, biochemistry Document type / Вид документа: Книга. Монографія Year / Рік видання: 2024 Place of publication / Місце видання: India. United Kingdom Publisher / Видавництво: PB International Author / Автор: Dr. Tsygankova Victoria Anatolyivna. Department for Chemistry of Bioactive Nitrogen-Containing Heterocyclic Compounds, V.P. Kukhar Institute of Bioorganic Chemistry and Petrochemistry of National Academy of Sciences of Ukraine, Ukraine. Language / Мова: English Size / Кількість сторінок:177 ISBN 978-93-48388-53-7 (Print), 978-93-48388-10-0 (eBook) |
|
|
Recent Developments in Chemistry and Biochemistry Research Vol. 9 / Eds. Dr. Tsygankova Victoria Anatolyivna.
This book covers key areas of microbiology and biotechnology. The contributions by the authors include goat margarine, pathogenic bacteria, disc diffusion method, gas chromatography-mass spectrometry, heptadecanoic acid, microbial sensitivity test, diarrheagenic pathogens, multiple drug resistant patterns, antimicrobial susceptibility, ameliorates α1-antitrypsin deficiency phenotype, CRISPR/Cas9 gene editing, protein aggregation, liver fibrosis, Qiagen RNeasy, hSERPINA1 gRNA, prostate cancer cells, RNA kinase, apoptotic signaling, biomarkers, apoptosis, c-Jun NH2-terminal kinases, antisense oligonucleotides, arbuscular mycorrhizal fungi, vesicular-arbuscular mycorrhiza, integrated nutrient management, agricultural biotechnology, lipid transfer proteins, programmed cell death, anti-microbial peptides, host-induced gene silencing, green synthesis, personalized medicine, bioactive nanoparticles, surface-enhanced Raman scattering, giant magneto-resistive, biosensing technologies, cell wall degrading enzymes, siderophore production, foliar blight management, microbial diversity, drought tolerance, moisture stress tolerant, deep-sea microbes, biodiversity conservation, biogeochemical cycles. This book contains various materials suitable for students, researchers, and academicians in the fields of microbiology and biotechnology. Keywords: хімія, біохімія, chemistry, biochemistry Document type / Вид документа: Книга. Монографія Year / Рік видання: 2025 Place of publication / Місце видання: India. United Kingdom Publisher / Видавництво: PB International Author / Автор: Dr. Tsygankova Victoria Anatolyivna. Department for Chemistry of Bioactive Nitrogen-Containing Heterocyclic Compounds, V.P. Kukhar Institute of Bioorganic Chemistry and Petrochemistry of National Academy of Sciences of Ukraine, Ukraine. Language / Мова: English Size / Кількість сторінок:146 ISBN 978-93-48859-42-6 (Print), ISBN 978-93-48859-56-3 (eBook) DOI: 10.9734/bpi/rpmab/v9 |
 |
The Monograph “Chemistry and Biochemistry: Research Progress Vol. 7” / Ed.Dr.Tsygankova This book covers key areas of chemistry and biochemistry. The contributions by the authors include human breast cancer cells, Schiff bases, semicarbazone ligands, X-ray crystallography, Nuclear magnetic resonance spectra, antioxidant activities, hydroxyl radical scavenging activity, dietary plant constituents, singlet oxygen, rapeseed oil, desmucilagination, continuous transesterification, zinc oxide nanoparticles, chitosan, photochemical decomposition, horseradish root peroxidase, N-(phosphonomethyl)glycine, photodecomposition products, Schiff base metal complexes, eco-friendly synthesis, thermal analyses, microwave heating technique. This book contains various materials suitable for students, researchers, and academicians in the fields of chemistry and biochemistry. Keywords: Chemistry and Biochemistry Document type / Вид документа: Книга. Монографія ISBN 978-81-989371-8-6 (Print),
ISBN 978-81-989371-6-2 (eBook).
|
 |
Біоактивні сполуки, нові речовини і матеріали – 2025 : колективна монографія / за загальною ред. Колодяжної А.О. – Київ: Інтерсервіс, 2025. – 378 с. У колективній монографії представлено роботи співробітників Інституту біоорганічної хімії та нафтохімії ім. В.П. Кухаря НАН України, а також науковців інших інститутів та університетів. Два розділи книги вміщують наукові праці з біоорганічної хімії, органічної хімії, нафтохімії, хімії високомолекулярних сполук тощо. У першому розділі представлені результати синтезу нових органічних сполук, дослідження їх реакційної здатності, прогнозування фармакокінетичних показників, вивчення біологічної активності, встановлення взаємозв’язку між структурою і активністю. Другий розділ знайомить з науковими розробками, що стосуються нових полімерних композицій різного призначення з покращеними цільовими характеристиками, адгезивних матеріалів багатоцільового застосування з широким температурним діапазоном, сорбентів забруднюючих речовин, нових паливних і мастильних матеріалів, каталізаторів олеохімічних перетворень, методів переробки антропогенних відходів. Книга призначена для широкого кола фахівців у галузі хімії та біології, а також аспірантів і студентів. Рекомендовано до друку Вченою радою Інституту біоорганічної хімії та нафтохімії ім. В.П. Кухаря НАН України (протокол № 12 від 28.08.2025 р.). Рецензенти: Keywords: органічна хімія, біоорганічна хімія, синтез, біоактивні сполуки, Document type / Вид документа: Книга. Колективна монографія ISBN 978-966-999-557-5 |
© 2026 IBOPC NAS of Ukraine